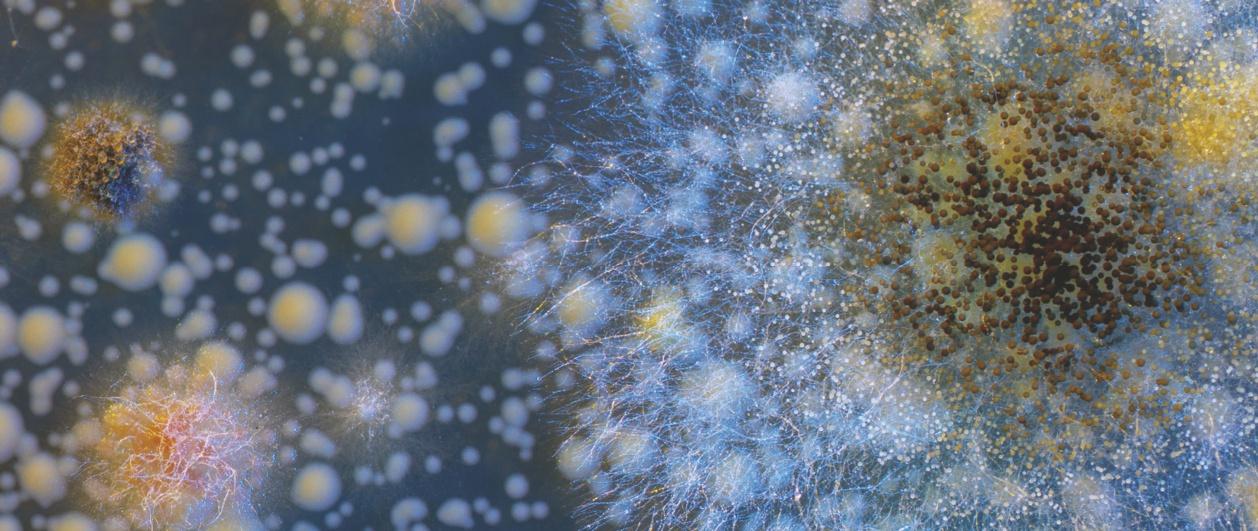

Beste docent,









Voor je ligt het inkijkexemplaar van Vivo. Vivo is de nieuwe biologiemethode voor de volledige onderbouw van vmbo-bk tot en met vwo-gymnasium, en voor vmbo-bovenbouw.
In dit katern tref je het eerste hoofdstuk van het havo/vwo-boek. Via handige ‘geeltjes’ ontdek je alles over Vivo en hoe de methode jou kan ondersteunen in de lespraktijk.
• Vivo laat inzien waarom
Als leerlingen snappen waarom ze iets leren, zijn ze veel gemotiveerder om te leren. In de lesstof en opdrachten van Vivo wordt de relevantie voor de leerling direct duidelijk.
• Vivo start vanuit samenhang
Kennis beklijft beter door inzicht in de verbanden tussen alles wat leeft. Vivo start daarom vanuit het grote plaatje en zoomt vervolgens in op processen en details.
• Vivo prikkelt het denken
Goede vragen zetten het denken in beweging. Daarom bevat Vivo veel activerende, makkelijk organiseerbare opdrachten, die het leren leuk maken.
Benieuwd naar Vivo?
Bel of mail Rick voor meer informatie en een presentatie bij jou op school. Of neem contact op met de klantenservice via thiememeulenhoff.nl/contact of telefoon (033) 448 3600.
Rick Potgens
r.potgens@thiememeulenhoff.nl
(06) 16 33 84 53
Dit zeggen docenten over Vivo
“Wij werken sinds kort met Vivo, het opstarten verliep prima! Vivo is een hedendaagse methode. De leerstof wordt vanuit het ‘grotere geheel’ aangeboden, waardoor leerlingen de stof in een grotere context leren plaatsen. In oude biologieboeken was het altijd lastig om de leerstof te verbinden aan andere thema’s. Daar is bij Vivo gelukkig goed over nagedacht. Elk hoofdstuk sluit af met de mogelijkheid tot herhaling en verdieping. Dat is echt fantastisch en op die manier kan ik het onderwijs beter afstemmen op de leerling.”
Marco Hartman, Montessori College Arnhem

“Wat ik heel leuk vind aan het hoofdstuk Planten is de paragraaf over het onderzoek aan stuifmeel. Dit gaf meer inzicht in de praktische kant van biologie. Dus een mooie relevante toevoeging. Die relevantie kwam overigens bij andere paragrafen ook mooi terug, met voorbeelden die goed aansluiten bij de belevingswereld van leerlingen.“
Birgit Hanssen, OSG de Hogeberg
“Wat ik merk is dat Vivo een mix heeft in de opdrachten. Gesloten vragen die vastigheid geven, maar ook dat leerlingen moeten leren om zelf na te denken. Die mix is wel heel fijn binnen de vragen.”
Liana van Lindenberg, Reggesteyn
“Fijn dat elk hoofdstuk begint met een actieve startopdracht. Daardoor heb ik de leerlingen meteen ‘aan’ staan. En door ‘het grote plaatje’ voor in het hoofdstuk, kan ik de klas makkelijk uitleggen hoe alles in de biologie met elkaar verbonden is. De leerwerkboeken zien er overzichtelijk uit, met prachtig beeldmateriaal!”
Marlies van den Hurk-Bakker, Eerste Christelijk Lyceum
BIOLOGIE 1 HAVO/VWO DEEL A





Vivo heeft boeken per niveau en leerjaar. Maar je kunt ook kiezen voor maatwerk. Je stelt dan je eigen boek samen. Je kunt ook eigen materiaal toevoegen.

COLOFON
Auteurs
Lisette van Engelen, Barend de Graaf, Marlies van den Hurk-Bakker, Rob Melchers, Jorinde Post, Annemarel Reiber-Elhorst, Willy Stein, Nora Walsarie Wolff-Cox, Bram Winkelman
Eindredactie
Ilse Gmelig
Taalredactie
Marcella Spithoven
Illustraties
Gemma Stekelenburg, Rogier Trompert, Marjolein Luiken
Ontwerp
Omslag: Carlo Polman - OudZuid Ontwerp
Binnenwerk: Tom Lamers - Reclamers
Opmaak
Crius Group, Hulshout


Omslagbeeld
Ajay Sapkota / EyeEm / Getty Images
Over ThiemeMeulenhoff
Vivo wordt gemaakt door ervaren docenten en de beste illustratoren.
ThiemeMeulenhoff ontwikkelt zich van educatieve uitgeverij tot een learning design company. We brengen content, leerontwerp en technologie samen. Met onze groeiende expertise, ervaring en leeroplossingen zijn we een partner voor scholen bij het vernieuwen en verbeteren van onderwijs. Zo kunnen we samen beter recht doen aan de verschillen tussen lerenden en scholen en ervoor zorgen dat leren steeds persoonlijker, effectiever en efficiënter wordt.
Samen leren vernieuwen. www.thiememeulenhoff.nl
ISBN 978 90 06 730 920
Eerste druk, eerste oplage, 2022
� ThiemeMeulenhoff, Amersfoort, 2022
Alle rechten voorbehouden. Niets uit deze uitgave mag worden verveelvoudigd, opgeslagen in een geautomatiseerd gegevensbestand, of openbaar gemaakt, in enige vorm of op enige wijze, hetzij elektronisch, mechanisch, door fotokopieën, opnamen, of enig andere manier, zonder voorafgaande schriftelijke toestemming van de uitgever.
Voor zover het maken van kopieën uit deze uitgave is toegestaan op grond van artikel 16B Auteurswet 1912
j° het Besluit van 23 augustus 1985, Stbl. 471 en artikel 17 Auteurswet 1912, dient men de daarvoor wettelijk verschuldigde vergoedingen te voldoen aan Stichting Publicatie- en Reproductierechten Organisatie (PRO), Postbus 3060, 2130 KB Hoofddorp (www.stichting-pro.nl). Voor het overnemen van gedeelte(n) uit deze uitgave in bloemlezingen, readers en andere compilatiewerken (artikel 16 Auteurswet) dient men zich tot de uitgever te wenden. Voor meer informatie over het gebruik van muziek, film en het maken van kopieën in het onderwijs zie www.auteursrechtenonderwijs.nl
De uitgever heeft ernaar gestreefd de auteursrechten te regelen volgens de wettelijke bepalingen. Degenen die desondanks menen zekere rechten te kunnen doen gelden, kunnen zich alsnog tot de uitgever wenden.
Deze uitgave is volledig CO2-neutraal geproduceerd. Het voor deze uitgave gebruikte papier is voorzien van het FSC®-keurmerk.Dit betekent dat de bosbouw op een verantwoorde wijze heeft plaatsgevonden.
Vivo maakt duurzame keuzes. De boeken worden CO2-neutraal in Nederland geproduceerd, op papier met FSC-keurmerk.
3
Hoofdstuk 1
1.1
1.2
1.3
Hoofdstuk 2 Inzoomen
2.1 Hoe zijn organismen opgebouwd?
2.2 Organen en weefsels bestaan uit cellen
2.3 De delen van een cel
2.4 De celkern
2.5 Cellen delen, groeien en veranderen
2.6 De kleinste organismen en virussen
2.7 Verbreding: Het DNA bepaalt
2.8 Verdieping: Cellen als fabrieken
2.9 Hoofdstukafsluiting
Hoofdstuk 3 Leven op aarde
3.1 Waardoor zijn er zoveel soorten?
3.2 Biodiversiteit
3.3 Stambomen en fossielen
3.4 Leven in het verleden
3.5 Evolutie
3.6 Uitsterven en nieuwe soorten
3.7 Verbreding: De wereld op zijn kop door Darwin
3.8 Verdieping: Evolutie van de mens
3.9 Hoofdstukafsluiting
Vivo is eenvoudig te gebruiken in je les. Elk hoofdstuk heeft een vaste structuur met basisstof en extra stof. Daarmee is differentiëren eenvoudig.
Deel B
Hoofdstuk 4 Bewegen
4.1 Hoe blijf je fit?
4.2 Spieren en pezen
4.3 Skelet
4.4 Botverbindingen
4.5 Blessures
4.6 Steunweefsels
4.7 Verbreding: Groei
Actief leren Register
Register
Achterin het boek vind je Actief leren, een reeks handige werkvormen om te oefenen met ‘leren leren’.
Er zijn altijd twee extra paragrafen. Ze gaan over fascinerende onderwerpen, leggen verbinding met onderwerpen buiten het hoofdstuk of gaan dieper in op een onderdeel van het hoofdstuk.
4.8 Verdieping: Skeletten vergelijken
4.9 Hoofdstukafsluiting
Hoofdstuk 5
4.8 Verdieping: Skeletten vergelijken Waarnemen en gedrag
5.1 Waarom reageer je zoals je reageert?
5.2 Zintuigen en zenuwstelsel
5.3 Zenuwcellen en vervoer van impulsen
5.4 Zien



5.5 Hormonen
5.6 Gedrag van dieren
5.7 Verbreding: Horen, ruiken, proeven en voelen
5.8 Verdieping: Verslavingen
5.9 Hoofdstukafsluiting
Hoofdstuk 6 Planten
6.1 Wat heb je aan planten?
6.2 Planten zijn overal
6.3 Fotosynthese en verbranding
6.4 Bladeren, stengels en wortels
6.5 Stevige stengels
6.6 Voortplanting
6.7 Verbreding: Aanwijzingen door stuifmeel
6.8 Verdieping: Planten groeien en bewegen
6.9 Hoofdstukafsluiting
4
HAVO/VWO ZO WERK JE MET VIVO 4
INHOUD 1
Deel A
biologie? 6
Waarom
Biologie,
9
wat heb je eraan?
Levende wezens 16
Verschillende organismen 25
Organismen en hun omgeving 34
Alles hangt samen 43
Biologisch onderzoek 50
Verbreding:
naar antwoorden 58
Verdieping: Extreme organismen 64 1.9 Hoofdstukafsluiting 71
1.4
1.5
1.6
1.7
Op zoek
1.8
INHOUD 2 HAVO/VWO

ZO WERK JE MET VIVO
Deel A
Hoofdstuk 7 Jouw omgeving en duurzaamheid
7.1 Hoe zorg je voor een duurzame leefomgeving?
7.2 Voedselketens en kringlopen
7.3 Populaties
7.4 Verspreiding van organismen
7.5 Leefomgeving in gevaar
7.6 Duurzaam en gezond leven
7.7 Verbreding: Plasticsoep en technologie
7.8 Verdieping: Natuur in Nederland
7.9 Hoofdstukafsluiting
Hoofdstuk 8 Voeding en verteren
8.1 Wat is gezond eten?
8.2 Voedingsmiddelen en voedingsstoffen
8.3 Van mond tot maag
8.4 Verteren, opnemen en uitscheiden
8.5 Gezond of ongezond
8.6 Eten en verteren bij dieren
8.7 Verbreding: Duurzame voeding
8.8 Verdieping: Microbiomen
8.9 Hoofdstukafsluiting
Hoofdstuk 9 Hart en bloedvaten
9.1 Hoe krijgt elk deel van je lichaam wat nodig is?
9.2 Bloedsomloop
9.3 Het hart
9.4 Het bloed
9.5 Transport van stoffen
9.6 Afweersysteem
9.7 Verbreding: Donororganen en transplantaties
9.8 Verdieping: Bloedsomloop bij dieren
9.9 Hoofdstukafsluiting
Deel B
Hoofdstuk 10 Ademhalen en verbranden
10.1 Waarom adem je?
10.2 Ademhalen
10.3 Gaswisseling
10.4 Gezonde longen
10.5 Verbranding en energie
10.6 Lichaamstemperatuur
10.7 Verbreding: Leven zonder zuurstof
10.8 Verdieping: Ademhaling bij dieren
10.9 Hoofdstukafsluiting
Hoofdstuk 11 Voortplanten en seksualiteit
11.1 Hoe denk jij over seksualiteit?
11.2 Uitwendige geslachtsorganen
11.3 Inwendige geslachtsorganen
11.4 Omgaan met seksualiteit en seks
11.5 Soa’s en voorbehoedsmiddelen
11.6 Voortplanten en zwangerschap
11.7 Verbreding: Zorg goed voor jezelf
11.8 Verdieping: Zo doen dieren het
11.9 Hoofdstukafsluiting
Hoofdstuk 12 Erfelijkheid
12.1 Wat heb je van je familie?
12.2 Overerven van eigenschappen
12.3 Stambomen
12.4 Genetische code
12.5 Evolutie door mutatie
12.6 DNA-technologie
12.7 Verbreding: Wil je het weten?
12.8 Verdieping: Kruisingen en kansen
12.9 Hoofdstukafsluiting
5 Vivo dekt de SLO-leerdoelen
volledig af. Zo ben je verzekerd van een compleet programma.
ZO WERK JE MET VIVO – De biologie van je leven
Je gaat aan de slag met Vivo. Bij Vivo ontdek je waarom het vak biologie belangrijk is voor jou, voor onze samenleving en onze planeet. Hieronder zie je alles wat je in Vivo tegenkomt.



waardoor kun je
5.1 WAAROM REAGEER JE ZOALS JE REAGEERT?

Aan het eind van deze paragraaf kan ik:
STARTEN MET HET HOOFDSTUK


• Het hoofdstuk start met de grote vraag. Deze vraag ga je aan de hand van het hoofdstuk beantwoorden.
• De hoofdstukvraag staat in een overzichtstekening: het grote plaatje Daarin zie je de samenhang met andere hoofdstukken en de belangrijkste zaken van dit hoofdstuk om te onthouden.
• Online vind je de Uitdaging. Dit is een grotere opdracht waarbij je de stof van het hoofdstuk gebruikt.











DE EERSTE PARAGRAAF
• In de eerste paragraaf ontdek je waarom het onderwerp van het hoofdstuk belangrijk is, en welke rol het onderwerp speelt in jouw leven. Ook ontdek je hoe het onderwerp samenhangt met andere onderwerpen in de biologie.



WERKEN MET DE PARAGRAFEN
• Bij de paragraaftitel zie je welke iconen uit het grote plaatje horen bij deze paragraaf.




























































• In de leerdoelen zie je wat je deze paragraaf gaat leren.
• Bij de practica gaat het om doen: je docent bepaalt welke practica je gaat doen. Je vindt deze online.











• In de startopdracht ga je meteen actief aan de slag met het onderwerp van de paragraaf. Zo ontdek je wat je al weet en begrijp je de stof die komen gaat sneller en beter.

6
H1 Waarom biologie? Keuzes maken H9 Hart en bloedvaten Bloedsomloop H4 • Bewegen Zintuig- en H2 Inzoomen Zenuwcellen Zintuigen laten je reageren op de omgeving De hersenen sturen alles aan Waar dit hoofdstuk om? Waarom reageer je zoals je reageert? Welke verbanden zijn er? HET GROTE PLAATJE INLEIDING Je wandelt op de Veluwe en opeens sta je oog in oog met een wild zwijn. Je schrikt en zet het op een lopen. Wat gebeurt er in je lichaam? Hoe weet je dat het een wild zwijn is? Waarom vlucht je weg en waar wordt die beslissing genomen? Hoe worden je beenspieren aan
Hoofdstuk 5 Waarnemen en gedrag
het werk gezet en
extra hard lopen? Natuurlijk kom je niet dagelijks een wild zwijn tegen, maar ook dan reageert je lichaam op prikkels. Hoe? Dit hoofdstuk laat het je zien!
• uitleggen wat gedrag betekent in de biologie. • uitleggen wanneer je bewust gedrag vertoont. • uitleggen wanneer je onbewust gedrag vertoont. • uitleggen wat het nut kan zijn van gedrag bij mensen en dieren. STARTOPDRACHT Wat weet je al over gedrag? Gedrag is een breed begrip. Wat weet jij al over gedrag? Maak samen met een klasgenoot een mindmap over gedrag. In het midden van de mindmap staat het woord ‘gedrag’. Zet hieromheen woorden en begrippen die volgens jullie met gedrag te maken hebben. © Shutterstock Jacob Lund Hoofdstuk 5 Waarnemen en gedrag Waarom reageer je zoals je reageert?
Je maakt
In Zo werk je met zie je kernachtig hoe Vivo is opgebouwd.
WERKEN IN HET BOEK OF ONLINE
























Je kunt aan de slag in je leerwerkboek of online. In je boek vind je alles wat je nodig hebt: theorie en opdrachten. Deze staan natuurlijk ook online, plus handige extra’s.
•
•
Hoofdstuk 5 Waarnemen en gedrag Zintuigen en zenuwstelsel
•
•

waar het geheugen zit.
3 Nummer II III IV V VI is het deel waarmee je tijdens voetballen besluit de bal in het doel te gaan schoppen. 4 Nummers II III IV V VI en dan II III IV V VI zijn op volgorde de delen waarmee je ervoor zorgt dat je tijdens voetballen de bal precies in het doel schopt.
5 Nummer II III IV V VI is het deel waarmee je voelt dat je de bal raakt met je voet.
6 Nummer II III IV V VI is het deel waarmee je de scheidsrechter hoort fluiten, omdat je buitenspel stond.
5 Snelle bromvlieg Op je boterham zit een dikke bromvlieg. Bah! Je probeert de vlieg weg te slaan, maar deze is allang weggevlogen op het moment dat je met je hand op de plek bent waar de vlieg zat. Toch sloeg je zo snel mogelijk! Hoe kan een vlieg veel sneller reageren dan dat jij kunt slaan? Verklaar dit met de bouw van het zenuwstelsel van bromvlieg en mens.
WERKEN MET DE PARAGRAFEN
• Blauwgedrukte woorden in de theorie zijn de belangrijkste begrippen

• In ‘Wist je dat?’-kaders staan weetjes en voorbeelden. Je ziet hoe het onderwerp van de paragraaf terugkomt in het dagelijks leven.
• Iedere paragraaf heeft zes basisopdrachten
Daarna zijn er altijd drie extra opdrachten
• Online krijg je na de zes basisopdrachten een advies op maat om verder te oefenen: Herhaling, Extra of Plus.
5.9 HOOFDSTUKAFSLUITING




























KEUZEMENU Hoe leer je de theorie en begrippen uit het hoofdstuk? En hoe leg je de juiste verbanden? Kies een opdracht uit het keuzemenu achter in je boek als hulp bij het leren.
Zintuigen laten je reageren op de omgeving
Waarom reageer je zoals je reageert? zijn er? Je ziet links de verbanden tussen dit hoofdstuk en de andere hoofdstukken. a Leg deze verbanden Hoofdstuk 5 Waarnemen en gedrag Hoofdstukafsluiting
De hersenen sturen alles aan Je maakt je eigen keuzes uit. Noteer je antwoorden in de vakjes. Je ziet rechts iconen die laten zien waar het om draait in dit hoofdstuk. b Leg in je eigen woorden uit wat je ziet en wat je hebt geleerd in dit hoofdstuk. Noteer je antwoorden in de vakjes. Je hebt in paragraaf antwoord gegeven op de grote vraag Waarom reageer je zoals je reageert? Kijk nog even terug naar wat je toen hebt geantwoord. Zou je je antwoord aanpassen na het doorlopen van dit hoofdstuk? Zo ja, wat zou je nu zeggen? Betrek in je antwoord de verbanden en de punten waar-het-om-draait uit het grote plaatje.
Zintuig- en zenuwstelsel kunnen je gedrag beïnvloeden
VERBREDING EN VERDIEPING
• Nieuwsgierig? Ga aan de slag met de extra stof. In de Verbredende paragraaf leg je de verbinding tussen dit hoofdstuk en andere thema’s. In de Verdiepende paragraaf ga je dieper in op de stof van het hoofdstuk.
HOOFDSTUKAFSLUITING
• Je kijkt terug op het grote plaatje. Begrijp je de verbanden en kun je de hoofdstukvraag beantwoorden met wat je hebt geleerd?
• Je kijkt terug op de leerdoelen. Wat gaat goed en waar moet je nog aan werken?
• Met de online proeftoets controleer je of je de theorie goed hebt geleerd.





























• In Actief leren vind je werkvormen om de theorie te onthouden en begrijpen.

7
Boek
Theorie
Opdrachten Online
Theorie
Opdrachten
•
•
•
•
De Uitdaging
Verder oefenen op maat
Practica
Proeftoets 4 Taken van de hersenkwabben Verschillende zaken worden in verschillende delen van het centrale zenuwstelsel verwerkt. Hieronder zie je zes verschillende delen van het centrale zenuwstelsel met een kleur en een nummer (I t/m VI). II III IV V VI Kies per beschrijving het deel van het centrale zenuwstelsel (I t/m VI) dat daarmee te maken heeft. Let op: Sommige hersendelen heb je niet of juist meerdere keren nodig. 1 Nummer II III IV V VI is het deel waarmee je alles wat je ziet verwerkt. 2 Nummer II III IV V VI is het deel
TERUG NAAR HET GROTE PLAATJE Waarnemen en gedrag Je ziet hier nog een keer ‘het grote plaatje’ uit de hoofdstukopening. H1 Waarom biologie? Keuzes maken H9 Hart en bloedvaten Bloedsomloop


Extra stof Hoofdstukafsluiting Basisstof HOOFDSTUK 1
INHOUD Het grote plaatje 8 1.1 Biologie, wat heb je eraan? 9 1.2 Levende wezens 16 1.3 Verschillende organismen 25 1.4 Organismen en hun omgeving 34 1.5 Alles hangt samen 43 1.6 Biologisch onderzoek 50 1.7 Verbreding: Op zoek naar antwoorden 58 1.8 Verdieping: Extreme organismen 64 1.9 Hoofdstukafsluiting 71 © Shutterstock / teguh santosa kedua
Waarom biologie?
Het mooiste natuurbeeld vind je in Vivo. Prikkelend natuurbeeld zorgt voor verwondering.




De Uitdaging is een grotere opdracht die je op veel manieren kunt inzetten. Als differentiatie, maar ook als vervanging van de toets.
DE UITDAGING

Bij elk hoofdstuk hoort een Uitdaging. Deze kun je doen als vervanging van één of meer paragrafen. Gebruik de leerstof om het probleem op te lossen!


INLEIDING



Het vak biologie gaat over het leven. Niet alleen over jouw leven, maar over alle leven op aarde. Wat is leven eigenlijk? Iedereen weet dat een steen niet leeft en een kikker wel. Toch is het nog niet zo gemakkelijk om te omschrijven wat leven is. Dit hoofdstuk gaat over leven en onderzoek, de twee zaken waar het bij het vak biologie om draait.
Elk hoofdstuk in Vivo start vanuit samenhang
Hierdoor kunnen leerlingen de leerstof beter plaatsen en begrijpen. In het grote plaatje staan de verbanden binnen de biologie en de belangrijkste zaken uit het hoofdstuk.
HET GROTE PLAATJE
H2 • Inzoomen Cellen
H3 • Leven op aarde Organismen
Er is steeds een prikkelende vraag die leerlingen in het hoofdstuk leren beantwoorden. De hoofdstukvraag is ook de titel van de eerste paragraaf.
over al het leven op aarde



Biologie, wat heb je eraan?


Welke verbanden zijn er?
Waar
draait het in dit hoofdstuk om?




Binnen de biologie hangt alles samen
H4 • Bewegen Botten en spieren
H7 • Jouw omgeving en duurzaamheid Leefomgeving
Biologie helpt je om eigen keuzes te maken
Biologisch onderzoek maakt nieuwe oplossingen mogelijk
8
Hoofdstuk 1 Waarom biologie?
In de eerste paragraaf ontdekken leerlingen waarom het onderwerp belangrijk is, en welke rol het speelt in hun leven Ook ontdekken ze hoe het samenhangt met andere onderwerpen in de biologie.
1.1 BIOLOGIE, WAT HEB JE ERAAN?

Aan het eind van deze paragraaf kun je:
• uitleggen waar biologie over gaat.
Heldere leerdoelen geven houvast bij het begrijpen en leren van de stof.
• uitleggen welke onderwerpen in je eigen leven met biologie te maken hebben.
• uitleggen hoe biologie samenhangt met andere vakken.
• uitleggen waarom biologisch onderzoek voor jouw leven belangrijk is.

STARTOPDRACHT
1 Jouw idee over biologie
Alle woorden hieronder hebben te maken met biologie. Welke woorden horen volgens jou bij elkaar?
Maak combinaties met de volgende woorden: beweging - dier - klimaat - landbouw - leven - mens - plant - voedsel - ziekte






Vergelijk je combinaties met die van een klasgenoot.
Je mag zoveel combinaties maken als je wilt (er is dus niet één goed antwoord per combinatie). Leg aan elkaar uit waarom jij deze woorden bij elkaar vindt horen.
THEORIE

Je hele leven is biologie
Je bent eigenlijk je hele leven bezig met biologie, vaak zonder dat je het doorhebt. Je bent ermee bezig als je een plant water geeft of de hond uitlaat. Je bent zelfs met biologie bezig als je naar school fietst (zie figuur 1).
Sterker nog: voor je geboorte ging het al over biologie.
Het vak biologie gaat namelijk over leven. Bij het vak biologie bestudeer je alles wat met leven te maken heeft. Als je meer over biologie weet, kijk je bewuster naar je eigen leven en alles wat om je heen leeft.

© Shutterstock / Panumas Yanuthai ©
ANP / David Rozing
Figuur 1 Je bent zelfs met biologie bezig als je naar school fietst.
9 Hoofdstuk 1 Waarom biologie? Biologie, wat heb je eraan? 1.1
Heldere vormgeving zorgt voor afwisseling en structuur, dat geeft rust en overzicht.
Een wereld vol leven


Je leeft in een wereld met heel veel verschillende soorten levende wezens. Van planten, dieren en mensen tot schimmels en bacteriën. Er is een enorme verscheidenheid aan levende wezens. Van potvissen die meer dan 40.000 kilo kunnen wegen tot micro-organismen die je alleen met een hele goede microscoop kunt zien. Er zijn bontgekleurde dieren, zoals de ijsvogel met zijn prachtige, opvallende veren. Maar je hebt ook dieren die hun best doen om juist niet op te vallen, zoals het groentje: een vlinder die je bijna niet ziet tussen groene bladeren. En dan zijn er ook nog dieren die hun kleuren aanpassen aan de omgeving. Bijvoorbeeld de kameleonspin die van geel naar wit en omgekeerd kan verkleuren (zie figuur 2).



Het beeld in Vivo heeft altijd een functie. Het versterkt, illustreert en legt uit.
In elke paragraaf ontdekken


leerlingen
waarom het onderwerp voor hen belangrijk is. Zo wordt het onderwerp relevant, dat motiveert.
Al die levende wezens hebben een eigen plaats om te leven. Sommige dieren leven vooral in de lucht, zoals vogels en vleermuizen. Andere leven in water, zoals orka’s, sponzen en algen. Er zijn ook dieren en planten die op het land leven, zoals kamelen en klaprozen.


In leven blijven
Bij het vak biologie kom je veel te weten over levende wezens, hoe zij leven tussen al die andere levende wezens, hoe zij zich voortplanten en hoe zij hun best doen om in leven te blijven.
Elk levend wezen is afhankelijk van zijn lichaam. Daarom onderzoek je bij biologie hoe het lichaam in elkaar zit en hoe het werkt. Als je dit weet, kun je begrijpen wat het lichaam nodig heeft om gezond te blijven. Je leert welke effecten voeding en bewegen hebben op het lichaam en hoe het lichaam zichzelf beschermt tegen beschadiging en ziekte.
© Shutterstock / Super Prin © Shutterstock /
Sharp
Jordon
Figuur 2 Een ijsvogel, een groentje en de kameleonspin op verschillende bloemen
© Shutterstock / Marek Mierzejewsk
© Shutterstock / Karolsejnova
10 Hoofdstuk 1 Waarom biologie? Biologie, wat heb je eraan? 1.1
Blauwgedrukte woorden zijn de belangrijkste begrippen

Een levend wezen kan alleen in leven blijven in de juiste omgeving. Dit noem je zijn leefomgeving (of milieu). Ook voor jou is de leefomgeving van levensbelang. Het mag om je heen bijvoorbeeld niet te warm of te koud zijn. En er moet voldoende water en voedsel zijn. Een mens kan slechts drie tot vier dagen overleven zonder water en drie weken zonder voedsel.
Mensen hebben hun leefomgeving aangepast om te overleven. Je woont misschien in een goed geïsoleerd huis met verwarming. Je kleren beschermen je tegen kou of juist tegen felle zon. Om voldoende voedsel te hebben zijn mensen gewassen gaan verbouwen en dieren gaan fokken. Tegenwoordig is er op grote schaal landbouw en veeteelt
De leefomgeving bepaalt dus of je kunt overleven én hoe je dat doet. Bij biologie onderzoek je daarom niet alleen het levende wezen zelf, maar ook zijn leefomgeving.
De natuur bestuderen
Biologie, natuurkunde en scheikunde zijn drie natuurwetenschappen. Ook aardrijkskunde valt daar soms onder. Bij deze vakken bestudeer je verschijnselen van de natuur. Wat is eigenlijk het verschil tussen deze vakken?
Bij het vak biologie leer je vooral over de levende natuur. Je verdiept je in levende wezens, in welke omgeving ze leven en hoe ze leven. Bij natuurkunde verdiep je je in de natuurwetten. Je leert bijvoorbeeld over zwaartekracht en geluidsgolven. Bij scheikunde leer je hoe stoffen zijn opgebouwd en hoe ze met elkaar reageren. En bij aardrijkskunde leer je onder andere over het klimaat en de bodem. Bij deze drie vakken gaat het dus over de niet-levende natuur.
Elk van deze vakken heeft kennis uit de andere vakken nodig, want de levende en de niet-levende natuur zijn sterk met elkaar verbonden. Je leert bij biologie bijvoorbeeld hoe levende wezens op warmte en droogte reageren en welke invloed zwaartekracht heeft op de groei (= natuurkunde). Ook leer je bij biologie hoe speeksel in je mond reageert met zetmeel uit een stukje brood (= scheikunde) en welke planten en dieren leven in een gebied met een zeeklimaat (= aardrijkskunde).

Onderzoek door biologen
In je dagelijks leven kom je regelmatig ontdekkingen tegen die door biologen gedaan zijn. Hoe komt het bijvoorbeeld dat de frietjes die jij eet zo lekker zijn? Onderzoekers gebruiken hun biologische kennis om uit te vinden welke aardappels de beste zijn om friet mee te bakken en hoe ze knapperig worden in plantaardige olie.

© EMS
© Shutterstock /
Figuur 4 Bij biologie verdiep je je in levende wezens, ook in hun gedrag.
Davdeka
11 Hoofdstuk 1 Waarom biologie? Biologie, wat heb je eraan? 1.1
Figuur 3 Je huid beschermt je lichaam.
Biologen doen ook onderzoek naar medicijnen. Je hebt dus voordeel van het werk van biologen wanneer je een paracetamol inneemt tegen hoofdpijn. Of wanneer je een vaccinatie krijgt tegen een ziekte, zoals het coronavirus of HPV (zie figuur 5).
Er zijn veel verschillende soorten biologen en andere professionals met biologische kennis. Ze voeren allemaal andere onderzoeken uit, zoals DNA-onderzoek of onderzoek naar virussen. Ook is er biologische kennis nodig bij onderzoeken naar bijvoorbeeld de invloed van klimaatverandering of de effecten van giftige stoffen op levende wezens.
WIST JE DAT?
Insecten



In 2050 zijn er naar schatting 10 miljard mensen op de wereld. Die mensen moeten allemaal eten om in leven te blijven. Maar is er dan wel voldoende voedsel op aarde? Biologen over de hele wereld houden zich hiermee bezig. Medewerkers van Wageningen University & Research onderzoeken hoe je insecten als meelwormen en sprinkhanen kunt gebruiken als voedsel. Hier zitten veel voordelen aan. Insecten stoten veel minder broeikasgassen uit dan het vee dat we nu eten. Ze planten zich snel voort en hun vlees is net zo voedzaam als dat van koeien of varkens. Maar hoe zorg je ervoor dat mensen een broodje sprinkhaan gaan bestellen?

OPDRACHTEN
2 Het vak biologie

In deze opdracht denk je na over het vak biologie.
a Waar gaat het vak biologie over?
Wist je dat?: leuke feitjes voor aan de keukentafel; hiermee kunnen leerlingen thuis over biologie vertellen.
b Doe deze opdracht met een klasgenoot. Blader door de hoofdstukken van Vivo.

Praat samen over de volgende vragen.
• Welke onderwerpen lijken je interessant om over te leren? Waarom?
• Welke vragen komen in je op als je naar de hoofdstukken van Vivo kijkt?
© Shutterstock / nicemyphoto
© ANP / Koen van Weel
Gefrituurde meelwormen zijn in Thailand een heel gewone snack.
12 Hoofdstuk 1 Waarom biologie? Biologie, wat heb je eraan? 1.1
Figuur 5 Dankzij biologisch onderzoek is er vaccinatie tegen HPV.
Verscheidenheid

Er zijn heel veel verschillende soorten levende wezens op deze wereld.
Maak een mindmap over de verscheidenheid in levende wezens op aarde. Denk hierbij aan grote, kleine, opvallende en gecamoufleerde wezens. Denk ook aan de wezens in het water, op het land, in de lucht en in de grond. En vergeet niet dat planten ook levende wezens zijn.
verscheidenheid in levende wezens op aarde
4 Wat is leven?
Biologie gaat over leven. Wat is leven eigenlijk precies? In deze opdracht bespreek je dit met je klasgenoten. Bekijk de foto en lees de tekst over het robothondje Aibo.
Sony’s robothond Aibo beweegt op een natuurlijke manier. Hij eet en hij loopt, net als een echte hond. Aibo kan met kunstmatige intelligentie zelfs leren van zijn baasje en een eigen karakter ontwikkelen. De robothond ontwikkelt zich op basis van hoe zijn baasje hem beloont, aait of straft. Hij leert je ook herkennen en gaat zelf terug naar zijn oplaadmandje.

Bespreek in tweetallen de stelling: “Aibo is een levend wezen”.
• Bedenk zoveel mogelijk argumenten vóór en tegen de stelling.
• Probeer elkaar te overtuigen.
• Wat is jullie conclusie?
3
© Getty Images / NurPhoto / Oleksa
13 Hoofdstuk
1.1
Aibo de robothond
1 Waarom biologie? Biologie, wat heb je eraan?
Verrassende opdrachten maken van biologie een leuk en relevant vak.
5 Biologie in jouw leven
Vivo heeft veel actieve opdrachten, want biologie is meer dan kennis reproduceren.
a Kijk eens uit het raam. Wat zie je buiten gebeuren dat te maken heeft met het vak biologie?
b Kijk eens rond in het klaslokaal. Wat zie je binnen gebeuren dat te maken heeft met het vak biologie?
6 Verbanden: biologie en andere vakken
Biologie is een natuurwetenschap. Het vak hangt samen met andere natuurwetenschappen, zoals natuurkunde en scheikunde, en ook met aardrijkskunde. In deze opdracht benoem je de overeenkomsten en verschillen tussen biologie en de andere vakken.
Met cirkels kun je verschillen en overeenkomsten weergeven.
Tip: Je mag internet gebruiken.
Pak drie vellen papier. Teken op elk vel twee overlappende cirkels zoals in het voorbeeld.

Schrijf in het overlappende deel de woorden die met beide vakken te maken hebben. Schrijf in de buitenste gedeeltes wat de verschillen zijn tussen de twee vakken. Doe dit voor de volgende vakken:
• biologie en natuurkunde
• biologie en scheikunde
• biologie en aardrijkskunde

14 Hoofdstuk 1 Waarom biologie? Biologie, wat heb je eraan? 1.1
Biologie in andere beroepen
Je hoeft geen bioloog te zijn om met biologie te maken te krijgen. In andere beroepen kun je ook te maken hebben met biologie. Lees de profielen.
Karsu Dönmez is een bekende zangeres, pianiste en televisiekok. Haar gerechten komen vooral uit de Turkse keuken.
Bertie Steur heeft een akkerbouwbedrijf in Zeeland. Ze verbouwt daar onder andere tarwe, vlas, graszaad, chicorei en suikerbieten. Ook lopen er varkens, kippen en paarden op haar boerderij. Diederik Gommers is arts in het Erasmus-ziekenhuis. Hij behandelt daar patiënten op de intensive care. Tijdens de coronacrisis lichtte hij mensen voor over het coronavirus en over wat hij zag op de intensive care.
Hanne Tersmette is boswachter. Via social media neemt ze kijkers mee in haar werk. Ze maakt video’s over bijvoorbeeld het spotten van ijsvogels en het helpen van insecten. Ook laat ze zien wat er uniek is aan natuurgebieden in Nederland, zoals Dwingelderveld.
Omschrijf voor ieder beroep welke biologische kennis diegene (nodig) heeft.
AFSLUITING
8 Biologie, wat heb je eraan?

Hier reflecteert de leerling op de hoofdstukvraag. In de hoofdstukafsluiting komt het hele grote plaatje terug.
De grote vraag van dit hoofdstuk is: ‘Biologie, wat heb je eraan?’
Wat is jouw antwoord op deze vraag? Gebruik in je antwoord de informatie van deze paragraaf.
7
15 Hoofdstuk 1 Waarom biologie? Biologie, wat heb je eraan? 1.1
1.2 LEVENDE WEZENS








Aan het eind van deze paragraaf kun je:
• de zeven levenskenmerken benoemen.
• uitleggen of iets levend, levenloos of dood is.
Aan dit icoon herken je over welk deel van het grote plaatje de paragraaf gaat.
• uitleggen wat biotische en abiotische factoren zijn en hoe deze van invloed zijn op organismen.

Bij deze paragraaf hoort de volgende practicumopdracht:
• De slak
Overleg met je docent of je dit practicum gaat uitvoeren.
STARTOPDRACHT
1 Op zoek naar leven
Online staan motiverende en makkelijk uitvoerbare practica Bij de practica gebruikt de leerling handige vaardigheidskaarten
Elke paragraaf begint met een startopdracht Leerlingen gaan actief aan de slag met het onderwerp van de paragraaf. Zo ontdekken ze wat ze al weten en begrijpen ze de stof die erna komt sneller en beter.
Een ruimteschip met wezens van een andere planeet landt op aarde. Verkenners gaan onderzoeken of er op aarde levende wezens voorkomen. Ze komen dieren tegen en laten al snel aan hun commandant weten dat er leven op aarde is.
a Op welke dingen kunnen de verkenners hebben gelet toen ze dachten dat ze levende wezens zagen?
Overleg in een groepje van 2-4 personen. Noem minimaal vijf dingen waar ze op hebben gelet.
Of de dieren bewogen, ademhaalden, aten, dronken, geluid maakten, zintuigen hadden of bijvoorbeeld reageerden op de verkenners.
Vivo besteedt aandacht aan samen leren, te herkennen aan het samenwerkingsicoon.
b Wetenschappers onderzoeken of er leven mogelijk is op Mars. Waar letten ze op bij dat onderzoek?
© Shutterstock /
Sophia Floerchinger
16 Hoofdstuk 1
1.2
Waarom biologie? Levende wezens
THEORIE

Wanneer is iets levend?
Een levend wezen noem je in de biologie een organisme. Maar wanneer is iets levend?
Je zegt dat iets levend is als het levenskenmerken vertoont. Sommige levenskenmerken zijn nodig om als organisme te blijven leven. Andere zijn nodig om als soort te blijven bestaan.
Er zijn zeven levenskenmerken.
• Organismen groeien. Jij bent zelf ook nog in de groei.
• Organismen voeden zich door voedingsstoffen uit hun leefomgeving op te nemen. Jij krijgt voedingsstoffen binnen door te eten en te drinken.
• Bij organismen vindt gaswisseling plaats. Dit is het opnemen van zuurstof en het afgeven van koolstofdioxide. Bij jou gebeurt dit tijdens de ademhaling (in- en uitademen).
• Organismen kunnen zich voortplanten en voor nakomelingen zorgen. Een ouder organisme sterft, maar de soort blijft bestaan.
• Organismen kunnen hun omgeving waarnemen en daarmee reageren op wat er gebeurt. Je kunt bijvoorbeeld zien, horen, ruiken, proeven en voelen.
• Organismen kunnen op veranderingen in hun omgeving reageren, meestal door te bewegen. Jij ziet bijvoorbeeld een auto van rechts aankomen en je remt af om op tijd te stoppen.
• Organismen kunnen afvalstoffen afgeven. Stoffen die het lichaam niet nodig heeft worden verwijderd, bijvoorbeeld door te zweten, plassen en poepen.
Wil je weten of iets een levend organisme is, dan onderzoek je of het één of meer levenskenmerken heeft. Een organisme hoeft niet alle levenskenmerken tegelijk te vertonen om levend te zijn.
Als je een watervlo onder de microscoop bekijkt, kun je bijna alle levenskenmerken waarnemen (zie figuur 1).
• De watervlo brengt met zijn poten voedsel naar zijn mond.
• Het hartje van de watervlo klopt.
• Er zitten eieren in de broedruimte aan de achterkant van de watervlo.
• De watervlo zwemt rond.
• Er komt poep uit de anus.
• Het zwarte oog van de watervlo draait rond.
oog (waarnemen)
mond (voeden)
eitjes (voortplanten)
pootjes en sprieten (reageren)
darm (afvalstoffen afgeven)
Figuur 1 Bij de watervlo kun je de meeste levenskenmerken waarnemen.
17 Hoofdstuk 1 Waarom biologie? Levende wezens 1.2
QR-codes verwijzen naar korte clips en animaties, die de theorie verlevendigen.
Levend, dood, levenloos



Een naaktslak kan ieder jaar 400 eitjes leggen (zie figuur 2). Stel je eens voor dat iedere naaktslak uit zo’n ei ook weer 400 eitjes zou leggen en de nieuwe naaktslakken daarna ook weer. Hoe zou onze planeet er na een paar jaar uitzien als al die slakken blijven leven?
Zoiets gebeurt niet, want in de natuur gaan veel organismen dood. Bijvoorbeeld door ziekten, ouderdom of doordat ze worden opgegeten.










De theorie is helder geformuleerd door ervaren schrijvers. Elk niveau heeft zijn eigen accent in theorie en opdrachten en wordt geschreven door niveau-specialisten.
Een dood organisme heeft geleefd en heeft de zeven levenskenmerken niet meer. Het verschil tussen levend en dood is soms lastig te zien (zie figuur 3 en 4).
Figuur 3 De schimmels op het brood zijn levend, maar is het brood levend, dood of levenloos?

Als iets nooit levenskenmerken heeft gehad, noem je het levenloos Voorbeelden van levenloze dingen zijn een glazen vaas, de tv en je telefoon.
Aan de hand van twee vragen kun je bepalen of een voorwerp levend, dood of levenloos is (zie figuur 5).
Figuur 4 Deze boom is door bevers doorgeknaagd. De boom lijkt dood, maar misschien blijven sommige delen leven.
Vraag1
Heeft het voorwerp één of meerdere levenskenmerken?
janee
Dan is het levend. Bestaat het voorwerp uit cellen of resten van cellen?
Vraag2
janee
Dan is het dood. Dan is het levenloos.
© Shutterstock / JRJfin
© Shutterstock / AJSTUDIO PHOTOGRAPHY
Figuur 2 Stel je voor dat alle naaktslakken blijven leven!
© Marlies van den Hurk - Bakker
Figuur 5 Levend, dood of levenloos? Stel jezelf deze vragen.
18 Hoofdstuk 1 Waarom biologie? Levende wezens 1.2
In de tweede vraag lees je dat je op cellen let. Cellen zijn hele kleine delen van een levend wezen. Of iets cellen of resten van cellen heeft, kun je moeilijk zien aan de buitenkant. Daarvoor doe je onderzoek met een microscoop.
Biotisch en abiotisch
Als je in een boom klimt, klim je in iets levends. Maar als je op een rots klimt, klim je op iets wat levenloos is. In de natuur is veel te vinden wat nooit heeft geleefd en dus levenloos is. Denk maar aan stenen, zand en water. Alles in een leefomgeving wat levenloos is, noem je abiotisch. Warmte, de luchtkwaliteit en bijvoorbeeld het zoutgehalte van het water zijn ook abiotisch.

Alles wat leeft of geleefd heeft, noem je biotisch. De natuur bestaat uit een combinatie van abiotisch en biotisch (zie figuur 6 en 7). Als je de bodem onderzoekt, vind je levende organismen, resten van dode organismen en levenloze grond van zand, klei en steentjes. De abiotische en biotische onderdelen in de natuur beïnvloeden elkaar en vormen samen de leefomgeving.

Organismen zijn afhankelijk van de omgeving waarin ze leven. Ze hebben te maken met verschillende omgevingsfactoren. Dat kunnen biotische factoren zijn, zoals soortgenoten en andere soorten dieren of planten. Herten en konijnen eten beide grassen en kruiden. Ze zijn elkaars voedselconcurrenten. Hoeveel grassen en kruiden er voor hen beschikbaar zijn, hangt af van abiotische factoren zoals temperatuur, water en voedingsstoffen in de bodem (zie figuur 8).
abiotische factoren
biotische factoren
vos/roofdier
ziekmakend
gras/voedsel
hert/concurrent
konijn/soortgenoot
© Marlies van den Hurk - Bakker
Figuur 6 Levenloze rotsen, levenloos water, dode bladeren en levende struiken
licht lucht water bodem temperatuur
organisme
konijn
Figuur 8 Een konijn is afhankelijk van abiotische en biotische factoren.
© Shutterstock / gowithstock
19 Hoofdstuk 1 Waarom biologie? Levende wezens 1.2
Figuur 7 Dood en levenloos: een houten stoel met ijzeren poten
WIST JE DAT?
Een echt koele kikker
Kikkers nemen de temperatuur van hun omgeving aan. Als de omgeving 15 graden is, dan is de kikker ook ongeveer 15 graden. In de winter graven de meeste kikkers zich in om te voorkomen dat ze helemaal bevriezen.
De boskikker doet dit anders. Als de temperatuur onder het vriespunt zakt, bevriest zijn hele lichaam. Zijn hart stopt zelfs met kloppen. Als je de boskikker in deze staat bekijkt, lijkt hij dood. Als de lente aanbreekt en de temperatuur stijgt, gebeurt er iets heel bijzonders. De kikker ontdooit en zijn hart begint weer te kloppen. Alsof hij uit de dood opstaat.
OPDRACHTEN
2 Levenskenmerken
In de afbeeldingen zie je vier van de zeven levenskenmerken.

Vul bij elke afbeelding het juiste levenskenmerk in.
Het mooie, bizarre en verbazingwekkende van de biologie komt ook aan de orde!

Elke paragraaf heeft zes basisopdrachten, die leerlingen zowel in het boek als online kunnen maken.

3 Levenskenmerken herkennen


Is een organisme dood als het niet alle levenskenmerken heeft?
◯ Ja, want een organisme leeft alleen als het alle levenskenmerken vertoont.
◯ Nee, want het organisme is pas dood als het niet meer reageert.





◯ Nee, want een levend organisme hoeft niet alle levenskenmerken te hebben.
 © Shutterstock / Marek Mierzejewski
De boskikker bevriest in de winter en ontdooit in de lente.
© Shutterstock / Marek Mierzejewski
De boskikker bevriest in de winter en ontdooit in de lente.
20 Hoofdstuk 1 Waarom biologie? Levende wezens 1.2
4 Levenskenmerken bij jezelf
Welke levenskenmerken vertoon jij op dit moment?
5 Tijdelijke levenskenmerken
Welke levenskenmerken vertonen de meeste organismen slechts een deel van hun leven? Leg uit.
6 Levend, dood of levenloos?
Zijn de voorwerpen levend, dood of levenloos?
Vul het juiste woord in.
Levend Dood Levenloos Perzik op sap ◯ ◯ ◯ Blik waar de perziken in zitten ◯ ◯ ◯ Gebraden kip ◯ ◯ ◯ Gefrituurde meelworm ◯ ◯ ◯ Rauwe biefstuk ◯ ◯ ◯ Brillenglas ◯ ◯ ◯ Slakkenhuis ◯ ◯ ◯ 21 Hoofdstuk 1 Waarom biologie? Levende wezens 1.2
Das en omgevingsfactoren
Bekijk de figuur. Je gaat een soortgelijke figuur maken voor een das.
Tip: Gebruik www.zoogdiervereniging.nl voor meer informatie.



Maak een tekening van een das met biotische en abiotische factoren. Schrijf bij elke factor een korte toelichting. Bij licht kun je bijvoorbeeld schrijven dat dassen nachtdieren zijn: zij zoeken hun voedsel ’s nachts.
Bespreek je werk met een klasgenoot.
Schrijven en tekenen is belangrijk in het leerproces bij biologie. In de opdrachten is hier veel aandacht voor.
7
licht lucht water bodem temperatuur abiotische factoren biotische factoren vos/roofdier ziekmakend organisme gras/voedsel konijn/soortgenoot hert/concurrent konijn
22 Hoofdstuk 1 Waarom biologie? Levende wezens 1.2
EXTRA OPDRACHTEN
8 Levenskenmerken waarnemen
a Denk eens aan een hond.
Na de zes basisopdrachten zijn er drie extra opdrachten, geschikt voor tempodifferentiatie.
Beschrijf met behulp van de zeven levenskenmerken hoe je kunt zien dat het dier leeft. Werk in tweetallen.
Gaswisseling: als de hond ademt, gaat de buik op en neer.
Waarnemen: als jij roept, spitst de hond haar oren. Ze hoort een geluid.
Online differentieer je ook op niveau, met vervolgopdrachten in Herhaling, Extra of Plus. Leerlingen krijgen advies welke vervolgopdrachten het beste passen. Daarna kiezen ze zelf een route. Zo werkt elke leerling op het eigen niveau.



b Denk nu aan een kamerplant en kijk nog eens naar de lijst met levenskenmerken. Ook planten kunnen al deze levenskenmerken vertonen.
Schrijf van elk levenskenmerk op hoe je dat kenmerk bij een plant kunt waarnemen.
23 Hoofdstuk 1 Waarom biologie? Levende wezens 1.2
Levenloos lichaam
“Er is een levenloos lichaam in een sloot gevonden.” In het nieuws wordt vaak gesproken van een levenloos lichaam.
Leg uit wat er niet klopt aan deze krantenkop. 10 Omgevingsfactoren
Een veldmuis leeft in een grasveld. Allerlei omgevingsfactoren hebben invloed op het leven van de muis.
Welke omgevingsfactoren zijn biotisch en welke zijn abiotisch?
Abiotisch Biotisch
Meer oefenen met de stof uit deze paragraaf? Kies online voor Herhaling of Plus.
9
Sneeuw ◯ ◯ Stenen ◯ ◯ Soortgenoten ◯ ◯ Bacteriën ◯ ◯ Gras ◯ ◯ Roofdieren ◯ ◯ Zonlicht ◯ ◯
24 Hoofdstuk 1 Waarom biologie? Levende wezens 1.2
1.3 VERSCHILLENDE ORGANISMEN
Aan het eind van deze paragraaf kun je:
• uitleggen in welke vier hoofdgroepen organismen ingedeeld worden.
• van een organisme vertellen of dit een plant, dier, bacterie of schimmel is.
• uitleggen dat er ‘goede’ en ‘slechte’ bacteriën zijn en van beide voorbeelden geven.
• uitleggen dat er ‘goede’ en ‘slechte’ schimmels zijn en van beide voorbeelden geven.
Bij deze paragraaf hoort de volgende practicumopdracht:
• De loep
Overleg met je docent of je dit practicum gaat uitvoeren.
STARTOPDRACHT
1 Welk dier is dat?
Organismen kun je indelen in vier groepen: bacteriën, schimmels, planten en dieren.

Dit ga je doen:
1 Werk in tweetallen.
2 De een neemt een organisme uit één van de vier groepen in gedachten. De ander stelt vragen.
3 Je mag alleen vragen stellen die de ander met ja of nee kan beantwoorden.
4 Is het organisme na tien vragen nog niet geraden? Geef dan het antwoord en draai de rollen om.
5 Voer de opdracht ieder minimaal twee keer uit.
Welke twee vragen leverden de meeste informatie op?
© Getty Images / i Stockphoto 25 Hoofdstuk 1 Waarom biologie? Verschillende organismen 1.3
Veel verschillende organismen
Overal om je heen leven organismen. Soms kun je ze duidelijk zien: een koe in de wei, een hoge boom, een vogel in de lucht of een vlieg tegen het raam. Er zijn ook organismen die zo klein zijn dat je ze niet eens ziet.
Organismen zijn er in allerlei vormen en maten. Alleen al het aantal soorten kevers op aarde is gigantisch. Tussen die soorten kevers is er verschil in kleur, vorm en grootte (zie figuur 1).
Figuur 1 Er zijn ongeveer 350.000 soorten kevers bekend. Hier zie je een klein deel ervan.
Indelen in vier hoofdgroepen
Al eeuwen verwonderen mensen zich over de organismen om hen heen. Er zijn heel veel verschillende organismen. Daarom bedachten biologen een manier om overzicht te houden: organismen indelen in groepen. Indelen doe je op basis van kenmerken, zoals kleur, vorm, wel of geen haren, wel of geen bloed, wel of geen poten.
Vroeger konden biologen alleen de organismen indelen die ze met het blote oog zagen. Van bacteriën had nog niemand gehoord. Ze waren simpelweg niet te zien. De uitvinding van de microscoop bracht daar verandering in. Sindsdien weten we dat er superkleine organismen bestaan. Door microscopisch onderzoek ontdekten biologen dat bacteriën en schimmels andere kenmerken hebben dan planten of dieren. Daardoor kun je vier hoofdgroepen maken: bacteriën, schimmels, planten en dieren.
Je kunt bacteriën, schimmels, planten en dieren indelen door naar de kenmerken van cellen te kijken. Er zijn ook andere kenmerken waarop je kunt letten.

THEORIE
© Shutterstock / Protasov AN
26 Hoofdstuk 1 Waarom biologie? Verschillende organismen 1.3
Bacteriën
Bacteriën zijn heel kleine organismen die eruitzien als staafjes, spiraaltjes of bolletjes. Een bacterie bestaat uit één cel. Bacteriën zijn eencellige organismen. Bacteriën komen overal op aarde voor. Het maakt niet uit of het vochtig, droog, koud of heet is.
Bacteriën zijn belangrijke opruimers in de natuur. Ze voeden zich namelijk met de resten van (dode) planten en dieren. Ze zetten deze resten om in voedingsstoffen die planten kunnen opnemen. Er leven bacteriën in en op je lichaam. Deze zijn onmisbaar voor je gezondheid. In je darmen bijvoorbeeld zitten darmbacteriën die helpen bij het verteren van je voedsel. Op je huid zitten bacteriën die je beschermen tegen schadelijke bacteriën van buitenaf. Je noemt ze daarom ‘goede’ bacteriën. Ook andere soorten bacteriën zijn nuttig voor mensen, bijvoorbeeld de bacteriën die nodig zijn bij de productie van zuurkool en yoghurt.

Sommige bacteriesoorten kunnen je ziek maken (zie figuur 3). Zulke bacteriën vernietigen of vergiftigen cellen in je lichaam. Je eigen lichaam kan die bacteriën meestal goed bestrijden. Als dat niet lukt, word je ziek.


© Shutterstock
Figuur 2 De vier hoofdgroepen van organismen
© Shutterstock / Dimarion © Shutterstock / Everett Collection
27 Hoofdstuk 1 Waarom biologie? Verschillende organismen 1.3
Figuur 3 Twee voorbeelden van schadelijke bacteriën: streptococcus en E.coli
Virussen


Griep en verkoudheid worden veroorzaakt door virussen. Ook wratten en een koortslip krijg je door virussen. Maar let op: virussen zijn geen bacteriën! Virussen zijn nog veel kleiner dan bacteriën. Ze bestaan niet uit cellen. Het zijn daarom geen levende organismen. Virussen overleven alleen in de cellen van organismen. Ze hebben dus altijd een organisme nodig. Heb je veel virussen in je lichaamscellen, dan kun je er goed ziek van worden.

WIST JE DAT?
Heel veel bacteriën






Op en in je lichaam leven ongeveer 40.000 miljard bacteriën. Samen wegen ze ruim één kilogram! In je dikke darm zitten de meeste bacteriën; daar is ook het meeste voedsel. Op je huid zitten zo’n 50.000 bacteriën per vierkante centimeter.

Schimmels
Sommige schimmels zijn microscopisch klein, sommige zijn juist heel groot. De grootste schimmel is zo’n 1650 voetbalvelden groot. Schimmels lijken op planten, maar ze zijn niet groen. Schimmels kunnen eencellig of meercellig zijn. Voorbeelden van eencellige schimmels zijn gisten (zie figuur 4). Meercellige organismen bestaan uit een heleboel cellen die samen een lichaam vormen. Meercellige schimmels bestaan uit lange, vertakte schimmeldraden. Bij veel soorten groeien hieruit paddenstoelen (zie figuur 5).
schimmeldraden
© Shutterstock /
© Shutterstock / ART-ur
vasara
Figuur 4 Microscopische foto van gistcellen. Gist is een eencellige schimmelsoort.
28 Hoofdstuk 1 Waarom biologie? Verschillende organismen 1.3
Figuur 5 De paddenstoel groeit uit schimmeldraden.
Een heksenkring (zie figuur 6) is een cirkel van paddenstoelen. Onder de grond van een heksenkring ligt een groot netwerk van schimmeldraden.

Net als bacteriën ruimen schimmels dode resten op in de natuur. Schimmels vind je overal: in de lucht, in het water, in de bodem en in en op planten en dieren. Ze zitten ook op en in jouw lichaam. Meestal kan dat geen kwaad, maar er zijn ook schimmels die kalknagels, jeuk of schilfers veroorzaken. Ook op voedsel zitten schimmels. Als deze schimmels het voedsel gaan ‘opruimen’, groeien ze en worden ze zichtbaar. Van dit beschimmelde voedsel kun je ziek worden.

Sommige schimmels zijn nuttig voor de mens. Er zijn schimmels die we eten, zoals champignons en de schimmel op blauwschimmelkaas. Met gist maken we bier en brood. Met behulp van andere schimmels maken we antibiotica. Dat zijn medicijnen tegen ziekmakende bacteriën.
Planten

Stel, je eet een appel, terwijl je in een linnen hangmat ligt die je tussen twee eikenbomen hebt gespannen. Dan maak je echt gebruik van planten. Planten leven overal op aarde: op het land en in het water. Ze leven op zand, op kleigrond of op andere planten. De meeste planten zijn groen en hebben stengels of takken, bladeren en wortels. Soms hebben ze bloemen en daarna zaden of vruchten (zie figuur 7).

 © Shutterstock / divedog
© Shutterstock / JAZ STUDIO
Figuur 7 Verschillende soorten planten
© Getty Images / iStock / NajaShot
Figuur 6 Een heksenkring is een cirkel van paddenstoelen.
© Shutterstock / nyker
© Shutterstock / divedog
© Shutterstock / JAZ STUDIO
Figuur 7 Verschillende soorten planten
© Getty Images / iStock / NajaShot
Figuur 6 Een heksenkring is een cirkel van paddenstoelen.
© Shutterstock / nyker
29 Hoofdstuk 1 Waarom biologie? Verschillende organismen 1.3
© Shutterstock / Dmitry Demkin
Planten zijn het voedsel van dieren. Deze planteneters worden weer gegeten door andere dieren. Planten zijn dus onmisbaar! Planten zijn ook belangrijk in de geneeskunde. In planten zijn stoffen ontdekt waarmee we verschillende medicijnen kunnen maken.


Veel plantensoorten zijn meercellig. Zelfs kleine planten als speenkruid bestaan uit enorm veel cellen (zie figuur 8). Maar er zijn ook eencellige planten, zoals boomalgen. Je ziet ze vaak als het groene laagje op muren en boomstammen.
Dieren
Er zijn heel kleine eencellige dieren, zoals het pantoffeldiertje (zie figuur 9). Er zijn ook heel kleine meercellige dieren, zoals het beerdiertje (zie figuur 10). De meeste dieren bewegen en alle dieren voeden zich met andere organismen. Je hebt vleeseters, planteneters en alleseters. Mensen horen bij de alleseters. Mensen eten namelijk zowel planten als dieren.
Tot nu toe hebben wetenschappers zo’n 2,1 miljoen soorten organismen beschreven, waaronder 1,5 miljoen dieren, 380.000 planten en 140.000 schimmels. Er zullen nog veel nieuwe soorten organismen ontdekt worden. Er zijn plaatsen op aarde waar onderzoekers nog nooit geweest zijn, zoals ondoordringbare regenwouden en diepe oceanen. Daar leven vast en zeker soorten die nog niet ontdekt zijn.

 © Shutterstock / Thorsten Schier
Figuur 8 Speenkruid bloeit in de lente.
© Getty Images / E+ / Nancy Nehrin
Figuur 9 Microscopische foto van het pantoffeldiertje, een eencellig dier
© Shutterstock / 3Dstock
Figuur 10 Microscopische foto van het beerdiertje, één van de kleinste meercellige dieren
© WESTON, J.N.J. et al. 2020
© Shutterstock / Thorsten Schier
Figuur 8 Speenkruid bloeit in de lente.
© Getty Images / E+ / Nancy Nehrin
Figuur 9 Microscopische foto van het pantoffeldiertje, een eencellig dier
© Shutterstock / 3Dstock
Figuur 10 Microscopische foto van het beerdiertje, één van de kleinste meercellige dieren
© WESTON, J.N.J. et al. 2020
30 Hoofdstuk 1 Waarom biologie? Verschillende organismen 1.3
Figuur 11 De vlokreeft is kort geleden ontdekt op grote diepte in de Stille Oceaan.
OPDRACHTEN
2 Schimmels
Schimmels vind je soms ook in de keuken.
a Noem drie voedingsmiddelen die snel schimmelen. En noem drie voedingsmiddelen die niet zo snel schimmelen.
b Kun je verklaren waardoor dit verschil ontstaat.
Tip: Je mag internet gebruiken.

3 Groepen organismen
Bij biologisch onderzoek is de microscoop enorm belangrijk.
Welke groepen organismen konden wetenschappers pas indelen na de uitvinding van de microscoop?
☐ bacteriën




☐ dieren

☐ planten




☐ schimmels
4 Fantasiedier

In de figuur zie je een fantasiedier. Je vindt er kenmerken van verschillende diersoorten in terug.
Noteer van dit dier de belangrijkste onderdelen. Noteer vervolgens achter elk onderdeel een dier dat dit onderdeel ook heeft.
Vergelijk en bespreek je antwoorden met een klasgenoot.
31 Hoofdstuk 1 Waarom biologie? Verschillende organismen 1.3
5 Voedsel bewaren
Er is een aantal manieren om voedsel langer te bewaren. Noem drie verschillende methoden. Geef aan waardoor die methoden werken.
6 Bacteriën en schimmels
Geef twee verschillen en twee overeenkomsten tussen bacteriën en schimmels.
7 Op het menu
Stel een menu samen met een voor-, hoofd- en nagerecht dat zowel bacteriën, schimmels, planten als dieren bevat. Maak hiervan een menukaart.
32 Hoofdstuk 1 Waarom biologie? Verschillende organismen 1.3
EXTRA OPDRACHTEN
8 Bacteriën om je heen
Dit zijn momenten in de ochtend van Naomi.
• Moment 1: Naomi poetst haar tanden met water uit de kraan.
• Moment 2: Naomi eet een kom yoghurt.
• Moment 3: Naomi eet een banaan en gooit de bananenschil in de GFT-bak.
Bacteriën spelen een rol op elk van de drie momenten. Welke rol spelen de bacteriën?
Moment 1:
Moment 2:
Moment 3:
9 Indelen
Er is een hoofdgroep van organismen die je in de lucht, in het water, in de bodem en op andere organismen kunt vinden. Sommige zijn meercellig en andere zijn eencellig.
Over welke organismen gaat het stukje tekst? ◯ bacteriën
10 Alexander Fleming
De arts Alexander Fleming onderzocht bacteriedodende middelen. Na een dag onderzoek vergat hij een schaaltje met bacteriën op te ruimen. Toen hij later het schaaltje wilde schoonmaken, zaten er plukjes schimmel in. Het schaaltje zat vol met bacteriën, behalve direct om die plukjes schimmel heen. Deze penseelschimmel bleek een bacteriedodende stof af te scheiden.

Er was nog veel nader onderzoek nodig, maar uiteindelijk leidde deze ontdekking tot een heel belangrijk medicijn: penicilline. Penicilline was het eerste antibioticum.
a In welke hoofdgroep horen de organismen waarmee penicilline wordt gemaakt?
b In welke hoofdgroep horen de organismen die met penicilline bestreden worden?
c De uitvinding van de microscoop was belangrijk voor het verklaren en bestrijden van allerlei ziekten. Leg dit uit.
Meer oefenen met de stof uit deze paragraaf? Kies online voor Herhaling of Plus.
◯ dieren ◯ planten ◯ schimmels
33 Hoofdstuk 1 Waarom biologie? Verschillende organismen 1.3
© Getty Images / Bettmann Archive
1.4 ORGANISMEN EN HUN OMGEVING
Aan het eind van deze paragraaf kun je:
• uitleggen dat organismen aan hun omgeving aangepast zijn.
• benoemen wat een soort is in de biologie.
• verschillende samenlevingsvormen van organismen noemen.

• uitleggen hoe verschillende soorten organismen samenwerken en/of van elkaar afhankelijk zijn.
STARTOPDRACHT
1 Een perfect aangepaste dromedaris
Denk je aan een woestijn, dan denk je aan hitte, zand en stof, gebrek aan water en voedsel. Misschien denk je ook aan karavanen met dromedarissen. De dromedaris is een eenbultige kameel die perfect is aangepast aan de extreme omstandigheden in woestijnen. Hij is daardoor in staat om mensen en goederen over heel grote afstanden door droge gebieden heen te vervoeren.
Werk in tweetallen.
Tip: Je mag internet gebruiken.
Welke aanpassingen heeft de dromedaris aan de omstandigheden in de woestijn?
Schrijf in 5 minuten zoveel mogelijk aanpassingen op. Je kunt denken aan uiterlijke kenmerken en aan gedragskenmerken (wat de dromedaris doet).
Welk tweetal vindt de meeste aanpassingen?
©
34 Hoofdstuk 1 Waarom biologie? Organismen en hun omgeving 1.4
Shutterstock / Bradley Marshall
THEORIE
Aangepast aan de leefomgeving
Op onze planeet zijn allerlei verschillende landschappen. Vochtige jungles, hete woestijnen, diepe oceanen, hoge bergen, moerassen, enzovoort. Bijna overal kun je organismen vinden en op al die plekken zijn ze anders. Een uilensoort die in extreem koude gebieden leeft, ziet er anders uit dan een uilensoort die in Nederland leeft (zie figuur 1 en 2). Een witte uil valt niet op in de sneeuw, een bruine uil valt niet op in een boom. Ze zijn goed gecamoufleerd: de kleur van hun veren past bij de kleur van de omgeving.
Dat is zeker het geval bij de kameleon (zie figuur 3). Kameleons leven vooral in tropische en subtropische bossen. Door de camouflage valt het dier niet op voor roofdieren. De dieren hebben nog meer aanpassingen aan de omgeving. De poten hebben precies de juiste vorm om zich vast te klampen aan takken. De ogen van de kameleon kunnen onafhankelijk van elkaar alle kanten op draaien. Hij ziet daardoor vanuit alle richtingen een predator (slang, roofvogel) of een prooi aankomen.

Een predator is een organisme dat op zijn prooi jaagt. Het jagen om op te eten heet predatie: een organisme (predator) vangt een ander organisme (prooi) en eet het op. Kameleons vangen met hun uitrolbare tong insecten zoals wandelende takken. Dreigt er gevaar, dan laat de kameleon zich vallen en doet alsof hij dood is. De kameleon heeft kenmerken en een leefwijze die goed passen bij zijn leefomgeving. En zo is het met alle organismen in de natuur.



Watervogels zijn aangepast aan leven op en bij het water. Zij smeren hun veren goed in met vet. Zo trekt het water niet in hun veren als ze naar vissen duiken. En boven water rollen de druppels makkelijk van hun veren af. Zo blijven ze droog. Een aalscholver is ook een watervogel (zie figuur 4). Hij heeft maar heel weinig vet om zijn veren mee in te smeren. Als hij in het water duikt, worden zijn veren dus nat.
 Figuur 1 De sneeuwuil leeft in het noordelijk poolgebied.
©
Getty Images / iStock / RobChris
Figuur 2 De bosuil leeft onder andere in Nederland.
© Shutterstock / Dominyk Lever
Figuur 3 De tweehoornkameleon is goed aangepast aan zijn omgeving.
© Shutterstock / Bouke Atema
Figuur 1 De sneeuwuil leeft in het noordelijk poolgebied.
©
Getty Images / iStock / RobChris
Figuur 2 De bosuil leeft onder andere in Nederland.
© Shutterstock / Dominyk Lever
Figuur 3 De tweehoornkameleon is goed aangepast aan zijn omgeving.
© Shutterstock / Bouke Atema
35 Hoofdstuk 1 Waarom biologie? Organismen en hun omgeving 1.4
Figuur 4 Een aalscholver moet regelmatig zijn veren drogen.
De aalscholver laat na het vissen zijn veren drogen, want vliegen met natte veren kost veel energie. Je zou denken dat de aalscholver niet goed is aangepast aan zijn omgeving.
Maar dat is niet zo. Juist omdat de aalscholver zwaar is en geen vette veren heeft, kan hij veel dieper duiken dan de andere watervogels. Zo vangt hij vissen die voor andere vogels onbereikbaar zijn. Doordat een aalscholver andere aanpassingen heeft dan andere watervogels, is er weinig concurrentie. De aalscholver kan daardoor beter overleven.
Zo is het overal in de natuur: organismen concurreren om voedsel, ruimte, water of licht. Elke soort is op zijn eigen manier aangepast aan de biotische en abiotische omgevingsfactoren. Daardoor kunnen er veel soorten naast elkaar bestaan.
Verschillende soorten
In de biologie wordt het woord ‘soort’ niet willekeurig gebruikt. Een soort bestaat uit organismen die zich onder natuurlijke omstandigheden onderling kunnen voortplanten en dan vruchtbare nakomelingen krijgen. Een bosuil en een sneeuwuil zijn verschillende soorten; zij kunnen zich niet onderling voortplanten. Maar een grijze wolf en een hond kunnen zich wel onderling voortplanten en vruchtbare nakomelingen krijgen (zie figuur 5). Ondanks alle verschillen kun je ze in de biologie tot dezelfde soort rekenen.

Manieren van samenleven

Lantaarnvissen leven diep in de oceaan of in donkere grotten waar geen licht komt. De vissen gebruiken lichtgevende bacteriën om andere lantaarnvissen in het donker te vinden. Deze bacteriën zitten in speciale organen onder de ogen van de lantaarnvis (zie figuur 6). De lantaarnvis en de lichtgevende bacterie zijn aangepast aan elkaar en hebben hier beide voordeel van. De lantaarnvis kan soortgenoten vinden, de bacteriën krijgen voedingsstoffen van de lantaarnvis. Zo leven deze verschillende soorten organismen hun hele leven samen.
Als twee verschillende soorten organismen langdurig met elkaar samenleven, noem je dat symbiose. Er zijn verschillende vormen van symbiose. Zo kan het zijn dat het samenleven voor beide soorten voordeel oplevert, zoals bij de lantaarnvis. Het samenleven kan ook voor één van de soorten geen voordeel opleveren of zelfs nadelig zijn.
 ©
Shutterstock / Jim Cumming
Figuur 5 Een grijze wolf en een poedel
© Shutterstock / Anna_Bondarenko
© Imageselect / Paulo de Oliveira
©
Shutterstock / Jim Cumming
Figuur 5 Een grijze wolf en een poedel
© Shutterstock / Anna_Bondarenko
© Imageselect / Paulo de Oliveira
36 Hoofdstuk 1 Waarom biologie? Organismen en hun omgeving 1.4
Figuur 6 Lantaarnvis in symbiose met lichtgevende bacteriën
Parasieten en gastheren
Heb je wel eens een teek gehad? Dan spreek je van parasitisme. Parasitisme is een vorm van symbiose, waar maar één van de twee soorten van profiteert. De andere soort ondervindt er nadeel van. Een parasiet is een organisme dat op of in een ander organisme leeft. Het organisme waar de parasiet op of in zit noem je de gastheer

Ook vlooien zijn parasieten. Teken en vlooien leven van het bloed van andere organismen. Meestal merkt de gastheer daar niet veel van, hoogstens heeft die een beetje jeuk. Soms kun je van een tekenbeet toch ziek worden. Sommige teken zijn namelijk besmet met een bacterie. Die krijgen ze in hun lichaam door bloed te zuigen van besmette knaagdieren of egels (zie figuur 7). De teek kan de bacterie overdragen op het volgende organisme waarvan hij bloed opzuigt. Bij mensen kan de bacterie de ziekte van Lyme veroorzaken. Je wordt dus niet ziek van de teek zelf, maar van de bacterie die hij in jouw bloed heeft gebracht. De teek is een parasiet die een parasiet overbrengt.
Teken leven in bossen, duinen, parken en tuinen, in hoog gras of tussen dode bladeren. Na een wandeling is het verstandig om jezelf op teken te controleren en ze op de juiste manier te verwijderen (zie figuur 8).

WIST JE DAT?
De ossenpikker helpt de neushoorn. Neushoorns zijn erg populair bij stropers, omdat hun hoorns veel geld waard zijn. Ze worden zelfs met uitsterven bedreigd. De dieren zien slecht, waardoor stropers gemakkelijk dichtbij kunnen komen. Behalve als er ossenpikkers aanwezig zijn. Ossenpikkers zijn vogels die teken en andere parasieten van de huid van de neushoorns pikken. Deze vogels zien een mens al van grote afstand aankomen en slaan dan alarm. De neushoorns hebben geleerd om daarnaar te luisteren. Ze reageren op het alarm door weg te rennen.
 © Getty Images / iStock / mtreasur
Figuur 7 Egel met teken. Sommige teken zijn besmet met bacteriën.
© Getty Images / iStock / mtreasur
Figuur 7 Egel met teken. Sommige teken zijn besmet met bacteriën.
© Shutterstock / Soleil Nordic
© Shutterstock / AfricaWildlife
Figuur 8 Zo verwijder je een teek met een pincet.
37 Hoofdstuk 1 Waarom biologie? Organismen en hun omgeving 1.4
Zwarte neushoorn met ossenpikkers
2 Organismen
Noteer bij elke omschrijving het juiste begrip.
• Organismen die samen vruchtbare nakomelingen kunnen voortbrengen behoren tot dezelfde:
• Een organisme heeft een uiterlijk waarmee het niet opvalt in de leefomgeving:
• Organisme dat op prooi jaagt om deze op te eten:
• Organisme dat op een hinderlijke manier samenleeft met een ander organisme:
• Organisme dat een ander organisme in of op zich draagt:


• Twee organismen van verschillende soorten die langdurig samenleven:
3 Leefomgeving
Bekijk het lijstje van organismen en hun kenmerken.
• Blauwe pijlgifkikker: Zijn omgeving moet warm zijn en zijn huid moet goed vochtig blijven. Hij eet kleine insecten.
• Laplanduil: Kan goed tegen kou en heeft bomen nodig om nesten in te bouwen.
• Europese haas: Kan goed tegen wind en regen. Kan niet tegen extreme kou en extreme hitte.
• De gewone grootoorvleermuis: Leeft vooral in open loof- en naaldbossen, waar hij tussen de bomen kan jagen. Hij kan niet tegen extreme kou en extreme hitte.
• IJswalvis: Leeft in ijskoud water, moet boven water ademhalen. Hij is voor bescherming tegen orka’s afhankelijk van het zee-ijs rond de Noordpool. Is daarnaast een heel goede zanger.
Bekijk de figuur. Je ziet verschillende leefomgevingen, met hun temperatuur en neerslag.
OPDRACHTEN
laag weinig neerslag hoog temperatuur veel toendra poolijs naaldbos woestijn struikvegetatie grasland naaldbos loofbos woestijn grasland tropisch loofbos tropisch regenwoud 38 Hoofdstuk 1 Waarom biologie? Organismen en hun omgeving 1.4
Geef in de tabel aan in welke leefomgeving(en) de dieren voorkomen. Werk in tweetallen.
Hints:
• Loofbos komt niet voor in het gebied waar de laplanduil leeft.
• De Europese haas komt niet voor in woestijnen en bossen.
4 Bladsnijdersmieren
De bladsnijdermieren hebben een ondergrondse ‘schimmelmoestuin’. Ze brengen er verse bladeren naartoe. Deze bladeren snijden ze met hun kaken eerst in heel kleine stukjes en geven het dan als voedsel aan bepaalde schimmels. Deze schimmel leeft op de verse bladeren en maakt voedzame bolletjes. Die bolletjes zijn het eten van de mieren. De mieren zorgen ervoor dat ‘hun’ schimmel niet overwoekerd wordt door andere schimmels. Zo beschermen ze hun schimmeltuin.

Heeft de schimmel voordeel of nadeel van deze voedselrelatie? En de mier? Kies de juiste antwoorden.
• Schimmel: heeft voordeel | heeft nadeel | geen voordeel of nadeel
• Mier: heeft voordeel | heeft nadeel | geen voordeel of nadeel
poolijs toendra naaldbos woestijn (gemiddelde temperatuur) struikvegetatie grasland loofbos woestijn (hoge temperatuur) grasland (savanne) tropisch loofbos tropisch regenwoud Blauwe pijlgifkikker ☐ ☐ ☐ ☐ ☐ ☐ ☐ ☐ ☐ ☐ ☐ Laplanduil ☐ ☐ ☐ ☐ ☐ ☐ ☐ ☐ ☐ ☐ ☐ Europese haas ☐ ☐ ☐ ☐ ☐ ☐ ☐ ☐ ☐ ☐ ☐ Gewone grootoorvleermuis ☐ ☐ ☐ ☐ ☐ ☐ ☐ ☐ ☐ ☐ ☐ IJswalvis ☐ ☐ ☐ ☐ ☐ ☐ ☐ ☐ ☐ ☐ ☐
© Getty Images / iStock / Ken Grif 39 Hoofdstuk 1 Waarom biologie? Organismen en hun omgeving 1.4
5 Sloot
In een bepaalde sloot zijn de abiotische factoren heel gunstig voor een kikkersoort. Toch worden er bij onderzoek maar weinig kikkers van deze soort geteld.
a Noem twee abiotische factoren die gunstig zijn voor kikkers. Je mag het opzoeken.
b Noem twee biotische factoren die er mogelijk voor zorgen dat er toch maar weinig kikkers in die sloot leven.
6 Huismus versus huiszwaluw
Huiszwaluwen bouwen nesten in open schuren en onder dakranden. Soms wordt zo’n nest veroverd door een huismus, die graag in dezelfde soort omgeving wil nestelen. Huismussen en huiszwaluwen leven in dezelfde omgeving en stellen dezelfde eisen aan hun omgeving en de plaats en het model van hun nest.

Waar is dit een voorbeeld van?
◯ camouflage
◯ concurrentie
◯ parasitisme
◯ predatie
7 Zombie-mieren
Scan de QR-code en bekijk het Planet Earth-filmpje van BBC.
Zijn de uitspraken juist of onjuist?
De schimmel in het filmpje is een parasiet.
De schimmel maakt paddenstoelen aan.
Het gedrag van de mier wordt beïnvloed door de schimmelinfectie, waardoor de mier (door omhoog te klimmen) de schimmel beter verspreidt.
De mier wordt zombie-mier genoemd, omdat er een steel uit zijn hoofd groeit.
Juist Onjuist
◯ ◯
◯ ◯
◯ ◯
◯ ◯
40 Hoofdstuk 1 Waarom biologie? Organismen en hun omgeving 1.4
© Shutterstock / Werner Baumgarten Een huismus bewoont een zwaluwnest.
EXTRA OPDRACHTEN
8
Malaria

De malariaparasiet is een eencellig organisme dat bij mensen de ernstige ziekte malaria kan veroorzaken. De malariamug is de tussengastheer van de malariaparasiet. Dat wil zeggen dat de mug wordt besmet met de parasiet, maar er niet ziek van wordt. Als een besmette malariamug een mens steekt, brengt hij de malariaparasiet over op deze persoon. Mensen zijn de gastheer van de parasiet. De malariaparasiet is heel erg soortspecifiek: alleen mensen worden ziek en alleen de malariamug brengt de parasiet over.
a Welk organisme veroorzaakt de ziekte malaria?
◯ malariaparasiet
◯ malariamug
◯ mens
b Welke twee gastheren heeft de malariaparasiet?
c Beantwoord de twee vragen met ja of nee.
• Kan de malariaparasiet zich verspreiden in een gebied waar geen mensen wonen?
• Kan de malariaparasiet zich verspreiden in een gebied waar geen malariamuggen leven?
9
Relaties tussen soorten
Bij sommige vormen van symbiose is het niet duidelijk of beide organismen er voordeel van hebben. Een voorbeeld zijn zeepokken die op de huid van een walvis vastzitten. De zeepokken hebben voordeel, want ze hebben een woonplaats, reizen mee, komen steeds in vers water en kunnen hun verspreidingsgebied vergroten. Voor zover bekend, heeft deze manier van samenleven geen nadelige gevolgen voor de walvissen.
In de tabel zie je zes mogelijkheden (a t/m f) van de invloed die twee soorten X en Y op elkaar kunnen uitoefenen. Soort X is de walvis is en soort Y is de zeepok. De invloed kan voordelig (+), nadelig (-) of neutraal zijn (0).
Hieronder staan vier mogelijke relaties tussen soorten.
Geef bij elke relatie aan welke regel van de tabel (a t/m f) van toepassing is.
a b c d e f Één heeft voordeel en de ander heeft geen nadeel ◯ ◯ ◯ ◯ ◯ ◯ Voordeel voor beide organismen ◯ ◯ ◯ ◯ ◯ ◯ Parasitisme ◯ ◯ ◯ ◯ ◯ ◯ Predatie ◯ ◯ ◯ ◯ ◯ ◯ © Getty Images / Moment RF Malariamug a b c d e f + + + 0 0+0 0Invloed van soort X op soort Y Invloed van soort Y op soort X 41 Hoofdstuk 1 Waarom biologie? Organismen en hun omgeving 1.4
Kerkuil
Muizen zijn het hoofdvoedsel van de kerkuil. De kerkuil vliegt bijna geruisloos, waardoor een muis hem niet hoort naderen. De kerkuil kan bijna zonder geluid vliegen dankzij een aanpassing aan zijn vleugels. De voorste vleugelveer heeft een rij kleine haken die het geluid dempen.


Kerkuil
Mensen die in de buurt van een windmolen wonen klagen soms over geluidsoverlast. Vergelijk een wiek van een windmolen met de voorste vleugelveer van een kerkuil.
Welke vorm moet zo’n wiek volgens jou krijgen om zo min mogelijk geluid te veroorzaken? Teken de vorm die de wieken moeten krijgen.
Meer oefenen met de stof uit deze paragraaf? Kies online voor Herhaling of Plus.
10
© Shutterstock / MZPHOTO.CZ
© Getty Images / iStock / KeithSzafranski
42 Hoofdstuk 1 Waarom biologie? Organismen en hun omgeving 1.4
Uilenveer ingezoomd
1.5 ALLES HANGT SAMEN
Aan het eind van deze paragraaf kun je:
• uitleggen dat je de natuur op verschillende niveaus kunt bekijken.
• uitleggen hoe deze niveaus met elkaar samenhangen.
• uitleggen wat een ecosysteem is en voorbeelden noemen.

• uitleggen wat een voedselkringloop is en voorbeelden noemen.
Bij deze paragraaf horen de volgende practicumopdrachten:
• De microscoop (1)
• De microscoop (2)
Overleg met je docent welke je gaat uitvoeren.
STARTOPDRACHT
1 Inzoomen vanuit het heelal
Onze aardbol is maar een klein onderdeel van het heelal. Bij het vak biologie bestudeer je de organismen op aarde. Daarbij zoom je steeds verder in op steeds kleinere onderdelen.
Dit heb je nodig:
• internetverbinding
• telefoon
• app om een fotocollage te maken
Dit ga je doen:
1 Zoek een foto van de aarde vanuit de ruimte.
2 Zoek andere foto’s waarbij je steeds een stapje inzoomt.
3 Maak een fotocollage. Begin met de foto van de aarde.
4 Bij je foto’s zitten in ieder geval een foto van een organisme en een foto van een cel.
5 Gebruik minimaal acht foto’s.
Maak de fotocollage.
© Shutterstock / oksana.perkins 43 Hoofdstuk 1 Waarom biologie? Alles hangt samen 1.5
THEORIE






Van organisme tot biosfeer Je kijkt een natuurfilm over de bruine beer. De film begint met een close-up van een berin. De camera zoomt uit en er komen twee jongen in beeld. De berin rent samen met haar jongen weg voor een andere bruine beer. Er leven meerdere bruine beren in dit gebied. Zo’n groep organismen van dezelfde soort die in een bepaald gebied leeft, noem je een populatie
De bruine beren delen hun bos met veel populaties van andere soorten. Ze vinden struiken met bosbessen, in de stam van een omgevallen boom zoeken ze naar de larven van kevers en de berin vangt een zalm. Alle populaties die samen in een bepaald gebied leven vormen een levensgemeenschap

ecosysteem



biosfeer







De camera zoomt verder uit. Je ziet dat het leefgebied van deze bruine beren een uitgestrekt bos in West-Canada is. In de zomer valt er veel regen en is het aangenaam warm. In de winter kan het heel koud zijn en ligt er meestal een dik pak sneeuw. Dan houden de beren hun winterrust. De levensgemeenschap in het bos vormt samen met de abiotische omgevingsfactoren een ecosysteem

levensgemeenschap

organisme


populatie

De camera zoomt nog verder uit. Je ziet allerlei ecosystemen, zoals gebergtes, steden, woestijnen en zeeën. Alle ecosystemen samen vormen de biosfeer. De biosfeer bestaat uit het bovenste deel van de aardkorst, het aardoppervlak met het oppervlaktewater en het laagste deel van de atmosfeer. De biosfeer bestaat uit alle delen van de aarde waar organismen leven (zie figuur 2).
Samenhang
Van klein naar groot kom je vijf niveaus tegen: organisme, populatie, levensgemeenschap, ecosysteem en biosfeer. De niveaus hangen sterk met elkaar samen. Als de abiotische omgevingsfactoren blijvend veranderen, zal het hele ecosysteem veranderen en verdwijnen er soorten uit de levensgemeenschap. Als bijvoorbeeld door opwarming van het zeewater de zalmen bij West-Canada verdwijnen, verdwijnt een belangrijke voedselbron voor de bruine beren. Daardoor wordt hun populatie steeds kleiner en uiteindelijk komen er misschien geen bruine beren meer voor in dat gebied.
©
Figuur 1 De bruine beer, van organisme tot biosfeer
Shutterstock / max dallocco
44 Hoofdstuk 1 Waarom biologie? Alles hangt samen 1.5
Figuur 2 De biosfeer van de aarde
Veel verschillende ecosystemen
Het klimaat en de bodem bepalen welk ecosysteem in een gebied voorkomt. Tropische regenwouden vind je in gebieden waar het altijd heel warm is en vaak regent. De kenmerken van dit ecosysteem zijn: dichte begroeiing, hoge bomen en heel veel organismen. Op delen van de aarde met een ander klimaat en een andere bodem vind je andere ecosystemen, zoals woestijnen, naaldbossen, steppen en savannen.
In Nederland heb je verschillende ecosystemen. Neem bijvoorbeeld de duinen. Belangrijke abiotische omgevingsfactoren in de duinen zijn het zout en de droge bodem. De bovenste laag van de bodem bestaat vooral uit zand dat zoutig is door de invloed van de zee. Het regenwater zakt snel naar de ondergrond. De bovenlaag is daarom vaak heel droog. Er leven weinig soorten organismen (zie figuur 3).


Een ander ecosysteem is de heide. De heide kan alleen bestaan als het onderhouden wordt door bomen en struiken weg te halen en door te begrazen met schapen. Als dat lukt, vind je op de heide enorm veel soorten organismen.
Ecosystemen hoeven helemaal niet zo groot te zijn. Neem een slootje of een klein moeras. De waterdieren en waterplanten vormen samen met de bodem, het water en de lucht ook een ecosysteem (zie figuur 5).
© Shutterstock / jan kranendonk
Figuur 3 Ecosysteem in de duinen vlakbij de zee
lucht riet lisdodde kattenstaart dotterbloem waterlelie water wilde eend libelle blauwe reiger poelkikker zoetwatermossel waterhoen rietvoorn bodem pijlkruid geelgerande waterkever
Figuur 5 Het ecosysteem van een moeras
© Shutterstock / INTREEGUE Photography
45 Hoofdstuk 1 Waarom biologie? Alles hangt samen 1.5
Figuur 4 Ecosysteem in de duinen verder van de zee af
De voedselkringloop in een ecosysteem
In een ecosysteem zijn organismen onderling afhankelijk van elkaar. Het is een systeem van eten en gegeten worden. Planteneters eten planten en krijgen zo voedingsstoffen van planten. Vleeseters eten planteneters en zo worden voedingsstoffen doorgegeven. Hetzelfde gebeurt als vleeseters andere vleeseters opeten.
Planten, planteneters en vleeseters gaan een keer dood. Dode resten zijn het voedsel van de bacteriën en schimmels in de grond. Zij maken daarbij stoffen die planten weer gebruiken als voedingsstoffen. Voedingsstoffen worden dus voortdurend doorgegeven. Je noemt dit een voedselkringloop (zie figuur 6). De pijlen tussen de verschillende organismen geven de richting van de voedselstroom weer.
schimmels

De samenhang verstoord
Soms wordt de samenhang in een ecosysteem verstoord. Bijvoorbeeld wanneer mensen bestrijdingsmiddelen gebruiken om landbouwgewassen te beschermen tegen ziekten. Veel bestrijdingsmiddelen zijn schadelijk voor insecten. Ze gaan ervan dood. Insecten zijn voedsel voor vogels en kleine dieren zoals muizen en egels. Als deze dieren te weinig insecten kunnen eten, neemt hun aantal af. Daardoor neemt ook het aantal roofvogels af dat deze kleine dieren eet.
Door het gebruik van bestrijdingsmiddelen raakt de voedselkringloop dus verstoord. Dat heeft een nadelige invloed op het hele ecosysteem.
 planten
planteneters
en bacteriën
planten
planteneters
en bacteriën
dode resten voedingsstoffen dode resten dode resten
vleeseters voedingsstoffen voedingsstoffen
Figuur 6 Voedselkringloop. Hierin worden voedingsstoffen doorgegeven.
© Shutterstock / Albert Beukhof
46 Hoofdstuk 1 Waarom biologie? Alles hangt samen 1.5
Figuur 7 Oehoenest met ouder en jong. De jongen hebben veel voedsel nodig.
Exoten
Wasberen zijn vanuit Noord-Amerika naar Duitsland gehaald zodat mensen op de wasberen konden jagen. In Duitsland zijn er al zo’n 1,5 miljoen en in Oost-Nederland worden ze steeds vaker gezien. Wasberen horen hier van oorsprong niet thuis. Ze hebben hier geen natuurlijke vijanden. Als de aantallen sterk toenemen, gaan ze concurreren met de bunzing en de marter. Dat zijn dieren die hier van nature wel voorkomen.

Organismen die vanuit een ver land hiernaartoe verhuisd zijn en een plekje in de natuur hebben gevonden, noem je exoten. Er zijn ook planten die uit een ver gebied zijn gekomen en het hier goed doen. Een voorbeeld is de Japanse duizendknoop. Deze groeit snel en verdringt andere soorten planten. De Japanse bladvlo wordt tegenwoordig ingezet om de Japanse duizendknoop te bestrijden. De ene exoot wordt bestreden met de andere exoot!
OPDRACHTEN
2 Niveaus in de biologie
Zet de niveaus in de biologie in de juiste volgorde van klein naar groot. Noteer de cijfers 1 t/m 5 in de vakjes.
▢ biosfeer
▢ ecosysteem
▢ levensgemeenschap
▢ organisme
▢ populatie
3 Onderdeel van de biosfeer?
Is een stad een onderdeel van de biosfeer? Kies alle goede antwoorden.
☐ Ja, omdat in steden allerlei levende organismen voorkomen.
☐ Ja, omdat alles waar leven op aarde is bij de biosfeer hoort.
☐ Nee, omdat de stad geen natuurgebied is.
☐ Nee, omdat de stad alleen uit abiotische omgevingsfactoren bestaat.
WIST JE DAT?
© Shutterstock / Vladimir Wrangel
47 Hoofdstuk 1 Waarom biologie? Alles hangt samen 1.5
De wasbeer is een exoot in Nederland.
Niveaus
Tot welk niveau kun je de volgende voorbeelden rekenen? Maak de juiste combinaties.
Die berkenboom heeft een witte stam.
Alle berken op de Veluwe.
Berken zijn goede nestelplaatsen voor vogels en insecten.
Berken en dennenbomen op de Veluwe hebben last van de droogte.
Berken komen over de hele wereld voor.
5 Onderzoek op niveau
• • biosfeer
• • ecosysteem
• • levensgemeenschap
• • organisme
• • populatie
Wetenschappers hebben de volgende vragen. Ze doen onderzoek om die vragen te beantwoorden.
Kies per onderzoeksvraag op welke niveaus het onderzoek plaatsvindt.
Organisme Populatie Ecosysteem Biosfeer
Waardoor neemt het aantal wolven in Nederland toe?
Wat is de beste watertemperatuur in een aquarium om een goudvis te houden?
Waardoor neemt het aantal wilde bijen in Nederland steeds verder af?
Welke effecten heeft een grote vulkaanuitbarsting in de atmosfeer op de wereldwijde plantengroei?
6 Voedselkringloop
Welke organismen in een voedselkringloop kun je vergelijken met een vuilnisdienst die voor recycling van het afval zorgt? ◯ bacteriën en schimmels ◯ planten
7 Voedselkringloop in de zee
◯ planteneters
◯ vleeseters
In het ecosysteem van de zee is een aantal organismen afhankelijk van elkaar.
Noteer bij ieder organisme het bijhorende cijfer uit de voedselkringloop.
voedingsstoffen
schimmels en bacteriën
algen garnaal orka vis zeehond
4
☐ ☐ ☐ ☐
☐ ☐ ☐ ☐
☐ ☐ ☐ ☐
☐ ☐ ☐ ☐
is die ene boom doodgegaan? ☐ ☐ ☐ ☐
Waarom
1 2 3 4 5
48 Hoofdstuk 1 Waarom biologie? Alles hangt samen 1.5
EXTRA OPDRACHTEN
8 Menselijk handelen
Lees de volgende voorbeelden van ecosystemen.
1 Een weiland in Nederland waar koeien op grazen. Het gras wordt gemaaid en bemest. De koeien staan een deel van het jaar op stal.
2 Een koraalrif in een oceaan. Het wordt bewoond door vele soorten organismen. Door de opwarming van de aarde worden de oceanen warmer. Daardoor sterft het koraal. Allerlei andere soorten organismen zullen er dan ook niet meer kunnen leven.
Leg bij ieder voorbeeld uit welke rol mensen hebben in dit ecosysteem.
9 Rotsen
Waarom zijn grote, harde rotsblokken in het binnenste van bergen geen onderdeel van de biosfeer?
◯ omdat er organismen op die rotsblokken leven
◯ omdat er geen organismen in die rotsblokken kunnen leven
◯ omdat die rotsblokken onderdeel zijn van de aarde
◯ omdat die rotsblokken abiotische omgevingsfactoren zijn
10 Voedselkringloop is verstoord
Dit schema geeft een voedselkringloop weer in een ecosysteem. Deze voedselkringloop bestaat uit vier populaties die onderling van elkaar afhankelijk zijn.
Wat gebeurt er als er door een ziekte veel organismen in populatie 2 doodgaan?
Kies alle goede antwoorden.
☐ Het aantal organismen in populatie 1 neemt af.
☐ Het aantal organismen in populatie 1 neemt toe.
☐ Het aantal organismen in populatie 3 neemt af.
☐ Het aantal organismen in populatie 3 neemt toe.
1 2 3 4 voedingsstoffen 49 Hoofdstuk 1 Waarom biologie? Alles hangt samen 1.5
Meer oefenen met de stof uit deze paragraaf? Kies online voor Herhaling of Plus.
1.6 BIOLOGISCH ONDERZOEK
Aan het eind van deze paragraaf kun je:
• uitleggen uit welke stappen een natuurwetenschappelijk onderzoek bestaat.
• uitleggen hoe je resultaten van een onderzoek overzichtelijk kunt weergeven in een tabel of diagram.
Bij deze paragraaf horen de volgende practicumopdrachten:
• Tabel en staafdiagram
• Tabel en lijngrafiek
• Zaden
• Kikkervisjes
Overleg met je docent welke je gaat uitvoeren.
STARTOPDRACHT
1 Verschillende schoenmaten
De schoenmaten van de leerlingen in je klas zijn niet allemaal hetzelfde. Hoe is de verdeling van schoenmaten in je klas? Wat is de grootste en kleinste maat? Je gaat het onderzoeken.

Dit heb je nodig:
• tekenvel A3
• stift
Dit ga je doen:
1 Werk in viertallen.
2 Overleg hoe je het onderzoek gaat aanpakken.
3 Voer het onderzoek uit.
4 Geef de resultaten overzichtelijk weer.
5 Vergelijk de weergave van je resultaten met de andere groepen.
Welk resultaat ziet er het meest overzichtelijk uit?
Noem twee argumenten.
© Shutterstock / Monkey Business Images 50 Hoofdstuk 1 Waarom biologie? Biologisch onderzoek 1.6
Biologisch onderzoek in Nederland
Bijna elke dag is er wel nieuws over de wolf. De wolf was verdwenen uit Nederland, maar is na 150 jaar weer terug (zie figuur 1). Onderzoekers van Wageningen University & Research doen veel onderzoek naar de wolf. Ze houden de wolvenstand nauwkeurig bij, ze onderzoeken waar ze nu leven, of de populatie zich uitbreidt en welke prooidieren ze eten.

Op de Veluwe lopen één of meer roedels (wolvenfamilies) rond. Uit onderzoek in Duitsland is bekend dat wolvenfamilies in hun eigen territorium vooral wilde dieren eten en minder vaak schapen doden dan zwervende wolven. Dat is goed nieuws voor schapenhouders. Biologen onderzoeken op welke manier het ecosysteem in Nederland kan veranderen als er een aantal roedels leeft. De onderzoeken zijn belangrijk voor het behoud van de wolf. Er wordt ook onderzocht op welke manier mensen zo min mogelijk last hebben van de wolven. Er zijn namelijk ook mensen die de wolf niet in Nederland terug willen.
Zelf biologisch onderzoek doen
Er zijn veel verschillende manieren van onderzoek doen. Als je met een vergrootglas een blad van een plant bekijkt en daarvan een tekening maakt, ben je ook bezig met onderzoek. Je doet dan een waarneming die je vastlegt met een tekening. Je kunt ook je eigen vraag bedenken en deze beantwoorden door zelf onderzoek te doen.
Bij biologie doe je op een natuurwetenschappelijke manier onderzoek. Bij natuurwetenschappelijk onderzoek neem je steeds dezelfde stappen. Elke stap begint met een vraag die je jezelf stelt.

Stap 1. De onderzoeksvraag
Welke vraag heb ik over een bepaald onderwerp?
Stel een zo nauwkeurig mogelijke vraag, waarop je met je onderzoek een antwoord kunt geven. Je noemt dat de onderzoeksvraag
Voorbeeld: Snijbloemen in een vaas moet je af en toe extra water geven. Je vraagt je af hoe het komt dat de snijbloemen water kunnen opnemen, terwijl ze geen wortels hebben. Je stelt de volgende onderzoeksvraag: Zijn de bladeren van snijbloemen belangrijk bij het opnemen van water?
Stap 2. De hypothese
Welk antwoord op mijn onderzoeksvraag verwacht ik?
Dit noem je de hypothese
Voorbeeld van een hypothese: Bladeren zijn belangrijk; zonder bladeren nemen snijbloemen minder water op uit de vaas.
Stap 3. De methode en materialen
Op welke manier ga ik dit onderzoeken? Hoe ziet de proef of het experiment eruit?
De methode bevat een beschrijving hoe je het onderzoek gaat uitvoeren. Ook noteer je de materialen die je erbij nodig hebt. Methode en materialen samen noem je het werkplan
THEORIE
© Shutterstock / Bildagentur Zoonar GmbH
51 Hoofdstuk 1 Waarom biologie? Biologisch onderzoek 1.6
Figuur 1 De Europese grijze wolf is na 150 jaar terug in Nederland.
Voorbeeld:
Materialen:
• twee dezelfde snijbloemen met bladeren
• twee reageerbuizen met water
• scherp mes
Methode:
• Ik doe in de reageerbuizen een gelijke hoeveelheid water.
• Ik snijd van één van de twee stengels de bladeren af.
• Ik zet de tulpen in de reageerbuizen (zie figuur 2).
• Ik noteer de waterstand aan het begin van het onderzoek.
• Na 24 uur noteer ik opnieuw de waterstand in beide buizen.
• Ik bepaal het verschil in waterstand van beide reageerbuizen.
Nu ga je het onderzoek doen, volgens het door jou beschreven werkplan. Tijdens de uitvoering noteer je de waarnemingen, zoals de waterstand aan het begin- en aan het eind.
Stap 4. De resultaten
Wat heb ik waargenomen en gemeten?
Na het onderzoek geef je de waarnemingen overzichtelijk weer in een tabel of diagram. Dit zijn de resultaten. Elke figuur, tabel of diagram geef je een titel. Zo nodig noteer je de betekenis van bepaalde onderdelen.
Voorbeeld: Je maakt van je metingen een overzichtelijke tabel (zie tabel 1) of diagram (zie diagram 1). Je noteert van beide reageerbuizen de waterstand aan het begin van het onderzoek. Je noteert ook de waterstand van beide reageerbuizen 24 uur later. Vervolgens bereken je bij beide snijbloemen hoeveel centimeter het water is gezakt.
Stap 5. De conclusie
Welke conclusie(s) kan ik uit mijn onderzoek trekken?
Je geeft met je conclusie antwoord op de onderzoeksvraag. Bij de uitleg gebruik je de resultaten van het onderzoek. Voorbeeld: Door de aanwezigheid van bladeren neemt een snijbloem meer water op dan een snijbloem zonder bladeren.
Stap 6. De discussie
Achteraf stel je vragen over je onderzoek.
Ging het onderzoek naar wens? Komt eruit wat ik verwacht had? Ging er iets fout? Wil ik er nog meer onderzoek naar doen? Dit noem je de discussie
Voorbeeld: Ook in de buis met de snijbloem zonder bladeren zakte de waterstand. Nam de plant water op of kwam dat misschien door verdamping? Dat kan een mooi vervolgonderzoek zijn.
Reageerbuis 1 (in cm) Reageerbuis 2 (in cm) Start 5 5 Eind 4 4,5 Verschil 1 0,5
Tabel 1 Waarnemingen bij een onderzoek met snijbloemen aan het begin en na 24 uur
0 6 5 4 3 2 1 tulp 1
2 waterstand (in
2 2 1
en tulp
cm) waterstand bij tulp 1 en
Diagram 1 Waterstand bij snijbloem 1 en snijbloem 2 bij de start (blauw) en na 24 uur (oranje) in cm
waterstand aan het begin
52 Hoofdstuk 1 Waarom biologie? Biologisch onderzoek 1.6
Figuur 2 Een onderzoek met snijbloemen
Let op: het komt vaak voor dat de conclusie anders is dan in de hypothese. Ook dat is belangrijke informatie: je toont aan wat in ieder geval niet waar is. Het kan ook zijn dat het onderzoek zelfs helemaal mislukte. Dat is niet erg. Je leert ervan. Als je weet wat niet werkt, kun je ook bedenken wat dan wel zou werken.
Nauwkeurig werken en vastleggen Tijdens je onderzoek ga je vaak op zoek naar gegevens over het onderwerp, bijvoorbeeld in de bibliotheek, op internet en in biologieboeken. Je noemt dit bronnenonderzoek Je gebruikt hierbij betrouwbare bronnen. Dat is een bron die informatie geeft die op waarheid berust.
Voorbeeld: Wat is er al bekend over de opname van water door planten? Je leest bijvoorbeeld dat water verdampt via de bladeren en dat dat invloed heeft op de wateropname.
Bij een uitgebreid onderzoek is het belangrijk om een logboek bij te houden. Daarin zet je nauwkeurig de gang van zaken tijdens het onderzoek. Met behulp van het logboek kun je na afloop het onderzoeksverslag schrijven.
OPDRACHTEN
2 Stappen van natuurwetenschappelijk onderzoek
Zet de stappen van natuurwetenschappelijk onderzoek in de juiste volgorde. Noteer de cijfers 1 t/m 6 in de vakjes.
▢ conclusie
▢ onderzoeksvraag
▢ werkplan
▢ resultaten
▢ discussie
▢ hypothese
3 Hypothese
Wat is een hypothese?
◯ de vraag die je met je onderzoek probeert te beantwoorden
◯ de beschrijving van wat je verwacht te vinden in je onderzoek
◯ de uitwerking van alle stappen en materialen in je onderzoek
◯ het antwoord op de onderzoeksvraag
53 Hoofdstuk 1 Waarom biologie? Biologisch onderzoek 1.6
Eetgedrag bonobo’s
Je wilt weten welke soorten fruit bonobo’s het liefste eten. Daarvoor doe je 5 dagen onderzoek in een dierentuin.

Maak een kort werkplan van alle dingen die je gaat doen in dit onderzoek. Gebruik de vaardigheidskaart
‘Natuurwetenschappelijk onderzoek doen’ voor het maken van een werkplan. Het werkplan mag ongeveer 100 woorden hebben.
5 Onderzoek wateropname
Je hebt na een onderzoek de conclusie getrokken dat een snijbloem (een tulp) met bladeren meer water opneemt dan een snijbloem zonder bladeren. Je hebt tijdens je onderzoek waargenomen dat ook in de buis met de snijbloem zonder bladeren de waterstand zakte. Je vraagt je af waardoor dat gebeurt. In de discussie aan het einde van je onderzoek krijg je een idee over een vervolgonderzoek.
a Wat is je onderzoekvraag?
b Wat is je hypothese?

c Hoe ga je dit onderzoeken?
6 Onderzoek pijnstillers
Een onderzoeker onderzoekt de werkzaamheid van een pijnstiller. Hij geeft een groep mensen met hoofdpijn allemaal een pijnstiller. Hij noteert na hoeveel tijd de pijnstiller werkt. Het blijkt dat na een halfuur de helft van de mensen geen hoofdpijn meer heeft. De conclusie van het onderzoek is dat het middel goed werkt. Wat is er niet goed aan dit onderzoek en deze conclusie?
4
© Shutterstock / Sergey Uryadnikov
54 Hoofdstuk 1 Waarom biologie? Biologisch onderzoek 1.6
Bonobo’s in de dierentuin
Broedvogeltelling
Een onderzoeker telt in een gebied het aantal broedende vogels van verschillende soorten. Hij telt in dat gebied 15 zwarte mezen (a), 10 boomkruipers (b), 4 grote bonte
2 sperwers

Vier diagrammen bij de vogeltelling
Wat is de beste manier om de aantallen broedende vogels in een diagram te zetten?
◯ diagram 1
◯ diagram 2
◯ diagram 3
◯ diagram 4
EXTRA OPDRACHTEN
8 Onderzoek naar pissebedden
Karel wil onderzoeken of pissebedden liever in het licht of in het donker zitten. De proefomgeving heeft een donker gedeelte (deel A) en een verlicht gedeelte (deel B). Hij laat de pissebedden in de ruimte rondlopen en registreert elke vijf minuten waar de pissebedden zich bevinden (zie tabel 1).
Pissebedden geregistreerd per gedeelte
Deel A (donker)
Deel B (verlicht)
7
0abcd 5 10 15 0 5 10 15 0abcd 5 10 15 abcd 0 5 10 15 20 2020 a b c d = = = = zwarte mezen boomkruipers grote bonte spechten sperwers a b c d = = = = zwarte mezen boomkruipers grote bonte spechten sperwers a b c d = = = = zwarte mezen boomkruipers grote bonte spechten sperwers abcd 1 2 4 3
spechten (c) en
(d).
25 5
1 © Getty Images
55 Hoofdstuk 1 Waarom biologie? Biologisch onderzoek 1.6
Tabel
/ ullstein bild
Halverwege het experiment doet hij het licht in ruimte B uit en meet weer op dezelfde manier de verblijfplaats van de pissebedden. Als hij naar de resultaten kijkt, ziet hij iets opvallends (zie tabel 2).
Pissebedden geregistreerd per gedeelte
Deel A (donker) Deel B (donker)
8 22
Tabel 2
Karel heeft nu een idee over de voorkeuren van pissebedden.
Welke idee is aannemelijk?
◯ Pissebedden zoeken het donker op.
◯ Pissebedden zoeken het donker en de warmte op.
◯ Pissebedden zoeken het licht op.
◯ Pissebedden zoeken het licht en de warmte op.
9 Nog meer pissebedden
Karel heeft onderzocht of pissebedden liever in het donkere gedeelte (deel A) van de proefomgeving zijn of in het verlichte gedeelte (deel B). Het resultaat van het onderzoek laat zien dat de pissebedden vaker in het donkere deel A van de proefomgeving zitten. Karel trekt de conclusie dat de pissebedden een voorkeur hebben voor het donkere gedeelte A. Zijn klasgenoot Eline zegt dat hij ook een keer het experiment moet doen waarbij beide delen A en B niet verlicht zijn. Karel zegt dat dat niet nodig is.
Wie heeft gelijk en waarom?
◯ Karel heeft gelijk, omdat de pissebedden dan niet kunnen kiezen.
◯ Karel heeft gelijk, omdat de pissebedden dan overal evenveel komen.
◯ Eline heeft gelijk, omdat je moet testen of de voorkeur voor het deel A misschien door iets anders wordt veroorzaakt.
◯ Eline heeft gelijk, omdat je een proef altijd meerdere keren moet herhalen.
10 De zaklantaarn doet het niet
Bekijk de tekening.
a Zet de gedachten van Tim in de juiste volgorde. Noteer de cijfers 1 t/m 10 in de vakjes.
▢ Als ik er een nieuw lampje in doe, dan gaat het licht schijnen.
▢ Als ik er een nieuwe batterij in doe, dan gaat het licht schijnen.
▢ De zaklantaarn doet het nog steeds niet.
▢ Hé, deze zaklantaarn doet het niet!
▢ Het komt doordat de batterij leeg is.
▢ Het komt doordat het lampje stuk is.
▢ Hoe komt het dat de zaklantaarn het niet doet?
▢ Ik doe een nieuw lampje in de zaklantaarn.
▢ Ik doe een nieuwe batterij in de zaklantaarn.
▢ Ja! De zaklantaarn doet het!
56 Hoofdstuk 1 Waarom biologie? Biologisch onderzoek 1.6
Onderzoek naar de zaklantaarn
b Welke gedachte hoort bij de onderzoeksvraag?
c Welke gedachten horen bij de hypothese?
d Welke gedachten horen bij het werkplan?
e Wat is jouw eigen conclusie bij de onderzoeksvraag?
Meer oefenen met de stof uit deze paragraaf? Kies online voor Herhaling of Plus.
1 2 3 4 5 8 6 9 7
57 Hoofdstuk 1 Waarom biologie? Biologisch onderzoek 1.6
1.7 VERBREDING: OP ZOEK NAAR ANTWOORDEN
Aan het eind van deze paragraaf kun je:
• enkele belangrijke ontwikkelingen noemen die hebben geleid tot de huidige kennis over het menselijk lichaam.
• uitleggen wat het verschil is tussen fundamenteel onderzoek en oplossingsgericht onderzoek.
• jouw mening geven over het vergaren en gebruiken van steeds meer kennis.
STARTOPDRACHT
1 Biologische ontdekkingen
Er worden al duizenden jaren biologische ontdekkingen gedaan. Veel van die ontdekkingen zijn nu algemene kennis, zoals de kennis over het menselijk lichaam en geneesmiddelen. In deze opdracht denk je na over die ontdekkingen. Wanneer denken jullie dat deze ontdekkingen gedaan zijn? Maak een tijdlijn.
Dit heb je nodig:
• knipblad biologische ontdekkingen achter in je boek

• schaar
Dit ga je doen:
1 Werk in tweetallen.
2 Knip de acht kaartjes uit.
3 Overleg wat een logische volgorde is.
4 Leg de kaartjes in die volgorde.
5 Vergelijk jullie oplossing met die van een ander tweetal.
6 Probeer samen met de andere groep tot de goede oplossing te komen.
7 Controleer jullie antwoord.
58 Hoofdstuk 1 Waarom biologie? Verbreding: Op zoek naar antwoorden 1.7
© Getty Images / Alexis Rosenfeld
THEORIE
In welke volgorde vonden vanaf 1500 de ontdekkingen, doorbraken en uitvindingen plaats?
Tip: Je mag internet gebruiken.
Een oplossing voor bijna iedere kwaal
Heb je al langere tijd buikpijn? Dan ga je naar de huisarts. Misschien krijg je medicijnen of moet je naar het ziekenhuis voor onderzoek. Inmiddels is dit bijna vanzelfsprekend. Dat komt doordat we goed weten hoe het menselijk lichaam in elkaar zit, hoe het werkt en dat het ziek kan worden van bijvoorbeeld micro-organismen.

Hoe komen we aan al die kennis? We hebben het te danken aan mensen die nieuwsgierig waren naar de werking van het lichaam. Zo nieuwsgierig dat ze op zoek gingen naar antwoorden. Vaak met technieken die in hun tijd ongebruikelijk waren.
De arts uit het oude Rome
Het is 200 jaar na Christus en een tiener uit het Romeinse rijk trekt de wijde wereld in om zoveel mogelijk kennis op te doen over het menselijk lichaam. Deze jongen is Claudius Galenus. Wanneer hij terugkomt, laat hij zijn kennis graag zien. Zo toont hij tijdens een presentatie een varken dat geen geluid meer kan maken. Hoe dat komt? Galenus heeft een zenuw afgebonden. Ook snijdt hij de ingewanden van een aap uit de buik en daagt zijn collega’s uit om het te repareren. Niemand weet hoe dit moet. Galenus laat graag zien dat hij het wél kan.
Dankzij deze presentaties krijgt Galenus een baan als arts. Eerst in het amfitheater, om gladiatoren te genezen. Daarna als persoonlijke arts van vier Romeinse keizers. Ook blijft Galenus onderzoeken hoe het lichaam in elkaar zit. Maar hij heeft een probleem: het is namelijk verboden om dode menselijke lichamen te onderzoeken. Daarom ontleedt hij talloze dieren. Hierdoor krijgt Galenus veel nieuwe inzichten. Zo komt hij erachter dat het lichaam aangestuurd wordt door de hersenen (en niet door het hart, wat tot dan toe gedacht werd). Ook bedenkt hij dat de ademhaling tot stand komt door spieren en zenuwen, al heeft hij geen bewijs. Al zijn ideeën schrijft Galenus op in boeken.

© ANP / Science Photo Library
59 Hoofdstuk 1 Waarom biologie? Verbreding: Op zoek naar antwoorden 1.7
Figuur 1 Een presentatie van Galenus
Eerst zien, dan geloven
1300 Jaar lang worden artsen opgeleid met de boeken van Galenus. Ze worden gezien als dé waarheid. Tot een Belgische onderzoeker gaat twijfelen. Deze onderzoeker is Andreas Vesalius. Hij leeft in de 16de eeuw en mag wel dode mensenlichamen onderzoeken. De boeken van Galenus kloppen niet met wat hij zelf ziet! Veel organen zijn verkeerd beschreven. De boeken blijken vol te staan met organen van apen en andere zoogdieren.

Vesalius besluit zelf boeken te schrijven over de bouw en werking van het menselijk lichaam. Hij beschrijft honderden fouten van Galenus en bewijst dat deze ideeën zijn gebaseerd op dieren en niet op mensen. Zelf onderzoekt Vesalius de lichamen van zowel overleden mensen (misdadigers die ter dood veroordeeld zijn) als dode en levende dieren. Door deze onderzoeken kan hij een gedetailleerd beeld schetsen van het lichaam. Terwijl Vesalius zijn ideeën opschrijft, wordt de boekdrukkunst uitgevonden. Zijn boeken worden hierdoor in grote hoeveelheden verspreid. Talloze wetenschappers lezen de boeken van Vesalius. Zijn ontdekkingen én manier van onderzoeken worden de nieuwe standaard. Na de ontdekkingen van Vesalius baseren wetenschappers zich niet meer op oude boeken. Ze gaan, net als Vesalius, zelf experimenteren en waarnemingen doen.
Een hele kleine nieuwe wereld
Sommige ontdekkingen zijn toevallig gedaan. Bijvoorbeeld na de ontdekking van de microscoop. Antoni van Leeuwenhoek handelt in lakens en wil goed kunnen zien hoe de kwaliteit van de draden is. Daarom maakt hij zelf een apparaatje waarmee hij voorwerpen kan uitvergroten: een kleine koperen microscoop.

Hij houdt de microscoop voor zijn linkeroog en ziet alleen wazige vormen. Daarom draait hij met zijn andere hand aan de schroef tot het beeld scherp is.
Van Leeuwenhoek bekijkt nog meer dingen met zijn microscoop. Zo ontdekt hij een hele nieuwe wereld, die eerder verborgen is gebleven. Hij ziet bacteriën en andere eencelligen. Ook bestudeert hij de structuur van spiervezels en het insectenoog.
© Getty Images
© Imageselect / Science Source / F
Figuur 2 Eén van de anatomieboeken van Vesalius
60 Hoofdstuk 1 Waarom biologie? Verbreding: Op zoek naar antwoorden 1.7
Figuur 3 De microscoop van Van Leeuwenhoek, met helemaal bovenaan het kleine, ronde lensje
Van kennis naar geneeskunde
Dankzij Vesalius en Van Leeuwenhoek kunnen wetenschappers het menselijk lichaam steeds uitgebreider beschrijven. Zo worden aan het eind van de 19de eeuw steeds meer ziekmakende bacteriën ontdekt. Dat leidt wel tot betere hygiëne, maar ziekten door bacteriën kunnen nog niet worden genezen. Pas in 1928 komt er een doorbraak. Op dat moment ontdekt Alexander Fleming een penicillineschimmel die ziekmakende bacteriën bestrijdt.
Vanaf dan komt de geneeskunde in een stroomversnelling. Er worden steeds meer medicijnen ontdekt en manieren gevonden om ziekten te bestrijden. Hierdoor neemt de waardering voor wetenschappelijk onderzoek toe.
Raadsels van nu en oplossingen van morgen
200 Galenus
Eerste boeken over de bouw en werking van het lichaam
1670 Van Leeuwenhoek
Uitvinding van de microscoop en waarneming van bacteriën en cellen
1600 Vesalius
Eerste boeken over het lichaam, gebaseerd op waarnemingen en onderzoek van het menselijk lichaam eind 19 eeuw
Diversen
Ontdekking ziekmakende bacteriën 1928
Fleming
Ontdekking penicilline, stof die werkzaam is tegen ziekmakende bacteriën
Dankzij onderzoek weten we nu in grote lijnen hoe mensen zijn gebouwd en hoe hun lichaam werkt. Ook kunnen we bepaalde ziekten genezen. We kunnen opereren, gebruiken medicijnen, onderzoeken DNA en passen zelfs DNA van cellen aan. Dankzij deze kennis kunnen we mensenlevens redden en het leven draaglijker maken voor mensen met een chronische ziekte.
Toch weten we nog lang niet alles en blijven onderzoekers op zoek naar antwoorden. Hoe kunnen we kanker genezen? Waarom wordt de ene mens wel dement en de andere niet? Hoe kunnen we zo lang mogelijk gezond en fit blijven? Hoe ontstaan virussen die ons ziek maken? Over de hele wereld wordt gezocht naar deze antwoorden.
De wetenschap staat dus niet stil. Soms komt het onderzoek voort uit pure nieuwsgierigheid. Je wilt bijvoorbeeld weten hoe iets in elkaar zit. Of je bent ergens zo in geïnteresseerd dat je het langere tijd wilt bekijken. Dit heet fundamenteel onderzoek Maar je kunt ook op zoek zijn naar een oplossing. Bijvoorbeeld naar een medicijn om de ziekte van Alzheimer te genezen. Je gaat dan heel gericht onderzoek doen. Dit heet oplossingsgericht onderzoek. Door al deze onderzoeken krijgen we steeds meer kennis over het lichaam en over manieren om ziekten te voorkomen en te genezen.
ᵈᵉ
61 Hoofdstuk 1 Waarom biologie? Verbreding: Op zoek naar antwoorden 1.7
Figuur 4 Tijdlijn van belangrijke gebeurtenissen
OPDRACHTEN
2 Eeuwenoud onderzoek
Galenus en Vesalius worden gezien als belangrijke onderzoekers, die veel hebben bijgedragen aan de kennis over het menselijk lichaam.
a Op welke manier kwam Galenus aan de kennis over het lichaam?
b Op welke manier kwam Vesalius aan de kennis over het lichaam?
c Hoe kwam Vesalius erachter dat niet alle beschrijvingen uit de boeken van Galenus juist waren?
3 Onderzoek leidt tot onderzoek
Dankzij penicilline konden veel zieke mensen genezen.
Scan de QR-code en bekijk in het YouTube-filmpje hoe Alexander Fleming de penicilline uitvond.
Waarom was deze uitvinding onmogelijk geweest zonder de ontdekking van Antoni van Leeuwenhoek?
4 Verschillende soorten onderzoek
Wat is het verschil tussen fundamenteel onderzoek en oplossingsgericht onderzoek?
62 Hoofdstuk 1 Waarom biologie? Verbreding: Op zoek naar antwoorden 1.7
Fundamenteel of oplossingsgericht?
a Is het onderzoek van Andreas Vesalius fundamenteel onderzoek of oplossingsgericht onderzoek?
Leg je antwoord uit.
b Was het onderzoek van Antoni van Leeuwenhoek naar de draad van zijn laken fundamenteel onderzoek of oplossingsgericht onderzoek?
Leg je antwoord uit.
6 Op zoek naar een oplossing
In onze tijd wordt ook nog veel onderzoek gedaan, zowel fundamenteel onderzoek als oplossingsgericht onderzoek. Denk bijvoorbeeld aan onderzoek naar medicijnen tegen kanker. Of onderzoek om vaccins te ontwikkelen.
Tip: Je mag internet gebruiken.
Ga op zoek naar een voorbeeld van oplossingsgericht onderzoek in onze tijd.
7 De toekomst van onderzoek
Dankzij wetenschappelijk onderzoek ontdekken we steeds meer over het menselijk lichaam. Maar moeten we ook al die kennis gebruiken?
Lees de stellingen, vorm je mening en discussieer erover met een klasgenoot.
1 Het is wenselijk om alle ziekten te genezen.
2 Er moet meer oplossingsgericht onderzoek gedaan worden dan fundamenteel onderzoek.
3 De wetenschap moet er alles aan doen om de mens onsterfelijk te maken.
Schrijf eerst argumenten vóór en tegen de stelling op. Ga dan met een klasgenoot in discussie. Komen jullie tot een gezamenlijk antwoord?
5
63 Hoofdstuk 1 Waarom biologie? Verbreding: Op zoek naar antwoorden 1.7
1.8 VERDIEPING: EXTREME ORGANISMEN
Aan het eind van deze paragraaf kun je:
• voorbeelden noemen van recordhouders in de natuur.

• uitleggen wat extremofi elen zijn en enkele voorbeelden noemen.
• uitleggen welk voordeel het organisme kan hebben door extreme aanpassingen.
STARTOPDRACHT
1 Groot, sterk en snel
• De slechtvalk, het snelste dier op aarde, haalt bij een duikvlucht een snelheid van (a) km/uur.
• De blauwe vinvis, het grootste dier dat ooit heeft geleefd, heeft een massa van (b) ton. (Een ton is 1000 kg.)
• De Afrikaanse olifant is met (c) ton het zwaarste landdier.
• De duizendpoot Eumillipes persephone, het insect met de meeste poten, heeft (d) poten.
• De schuimcicade (spuugbeestje) kan relatief het verst springen, (e) keer zo ver als zijn lichaamslengte.
• De Onthophagus taurus, een kever, kan (f) keer zijn eigen gewicht trekken.
• Een sidderaal kan stroomstoten van (g) volt afgeven.
a Schat of zoek op internet bij elk dier het getal dat ingevuld moet worden. Tel daarna alle getallen bij elkaar op. Werk in tweetallen. Wie heeft de meeste antwoorden goed en wie komt het dichtst bij het juiste totaal?
b Hoe ver zou iemand van 160 cm kunnen springen met hetzelfde vermogen als de schuimcicade?
◯ 160 meter
◯ 16 meter
◯ 1600 centimeter
◯ 1600 meter
64 Hoofdstuk 1 Waarom biologie? Verdieping: Extreme organismen 1.8
© Shutterstock / Harry Collins Photography
THEORIE
Recordhouders in de natuur


Er zijn bacteriën die kleiner zijn dan een duizendste deel van één millimeter. Kun je je voorstellen hoe klein dat is? Maar er zijn ook schimmels die tientallen vierkante kilometers groot zijn. Sommige organismen zijn zó extreem dat ze in Guinness World Records staan. Er zijn allerlei recordhouders te vinden met extreme eigenschappen. Recordhouder stinken is de reuzenaronskelk (zie figuur 1). De geur van de bloem lijkt op de stank van rottend vlees. De plant trekt hiermee aasvliegen en aaskevers aan, die zijn stuifmeel verspreiden.

Er is ook een recordhouder met de grootste ogen: de ogen van de kolossale inktvis kunnen wel 60 centimeter groot worden. Daarmee kan de inktvis zijn prooidieren goed vinden in de donkere diepzee.
Wie is de grootste?
Wat is het grootste organisme? Je zou op deze vraag kunnen antwoorden met: de blauwe vinvis (zie figuur 2). Dat dier is ongeveer 28 meter lang en weegt rond de 140.000 kilogram. Maar de grootste reuzensequoia, een naaldboomsoort in Noord-Amerika, doet daar nog een schepje bovenop (zie figuur 3). Deze boom weegt 1.500.000 kg (1,5 miljoen kg). De grootste reuzensequoia's zijn 110 meter hoog. Als je alleen naar de afmeting kijkt, is het


schimmel. In Amerika werd een honingzwam (zie
schimmeldraden van bijna 9 vierkante kilometer
grootste organisme waarschijnlijk een
figuur 4) ontdekt met ondergrondse
(km2) in oppervlakte.
© Shutterstock / Oleg Bakhirev
© Shutterstock / Isabelle
Figuur 3 De reuzensequoia is een boom van meer dan 100 meter hoog.
OHara
Figuur 1 De reuzenaronskelk, Engelse naam: corpse flower (lijkenbloem) © Shutterstock / Chase Dekker
Figuur 2 De blauwe vinvis is het grootste dier.
© Shutterstock / Matauw
65 Hoofdstuk 1 Waarom biologie? Verdieping: Extreme organismen 1.8
Figuur 4 Een honingzwam heeft een enorm ondergronds netwerk van schimmeldraden.
Wie is de oudste?
Een Bristlecone Pine (een naaldboomsoort) leeft op de boomgrens in de bergen van de Rocky Mountains in de Verenigde Staten (zie figuur 5). Het oudste exemplaar is ongeveer 4.500 jaar oud. Deze boom was al 100 jaar oud toen de farao’s in het oude Egypte aan de macht waren!


De oudste levende vis die ooit is gevonden is de Groenlandse haai (zie figuur 6). Dat was een vrouwtje. Het meten van de leeftijd van deze haaien is moeilijk. Wetenschappers denken dat het gevonden vrouwtje bijna 400 jaar oud was.
De haaien leven in heel koud water en de processen in hun lichaam gaan heel langzaam. Daardoor gaat het lichaam lang mee en kan de haai dus heel oud worden.
Tip: In dit filmpje leer je meer over de Groenlandse haai: Oldest Shark in the World

WIST JE DAT?
Zwaarste en oudste organisme
De Amerikaanse ratelpopulier heeft een netwerk van wortels. Uit deze wortels ontstaan steeds nieuwe bomen. Alle nakomelingen zijn ontstaan uit de wortels van dezelfde boom. Ze zijn verbonden via hun wortels. Eigenlijk is het dus één organisme. Deze grote groep bomen weegt wel 6 miljoen kilogram. De leeftijd van zo’n oude groep bomen wordt geschat op 80.000 jaar. De groep kan zo oud worden, omdat een oud gedeelte kan afsterven zonder dat de hele groep doodgaat. Er groeien steeds weer nieuwe bomen en het organisme blijft bestaan.
© Getty Images / Moment RF / Piriy
Figuur 5 De Bristlecone Pine kan wel 4.500 jaar oud worden. © Shutterstock / Dotted Yeti
Figuur 6 De Groenlandse haai wordt honderden jaren oud dankzij het koude water.
© Shutterstock / Danita Delimont
66 Hoofdstuk 1 Waarom biologie? Verdieping: Extreme organismen 1.8
Al deze bomen zijn eigenlijk één organisme.
Wie is de giftigste?
Veel organismen zijn giftig om te voorkomen dat ze worden opgegeten. Ze gebruiken het gif als bescherming. Een voorbeeld hiervan is de pijlgifkikker (zie figuur 7). In en op de huid zit een heel sterk gif. Zijn felle kleuren moeten roofdieren afschrikken: 'Pas op! Ik ben giftig!'. De inheemse bevolking in Zuid-Amerika wreef de pijlpunten over de huid van pijlgifkikkers. Als zo’n pijl met gif in een dier of ander mens terechtkwam, stierf deze razendsnel. Pijlgifkikkers zijn zo giftig doordat ze veel giftige mieren en kevers eten.
In Nederland kun je in de natuur zomaar één van de giftigste paddenstoelen ter wereld tegenkomen: de groene knolamaniet (zie figuur 8). Hij lijkt op een eetbare soort: de weidechampignon. Dat maakt hem nog gevaarlijker, omdat je je dus snel kunt vergissen. Het eten van 30 gram groene knolamaniet kan al dodelijk zijn!


Er zijn ook organismen die gif gebruiken om een prooi te doden. De westelijke taipan, een slangensoort uit Australië, produceert het sterkste en dodelijkste gif van alle slangen (zie figuur 9). De taipan is erg schuw en zal eerder wegkruipen dan bijten.
De zwarte mamba is ook een gifslang (zie figuur 10). Hij is iets minder giftig dan de westelijke taipan, maar veroorzaakt meer dodelijke slachtoffers. De zwarte mamba is namelijk veel sneller en agressiever. Daardoor worden meer mensen door een zwarte mamba gebeten dan door een binnenlandse taipan. De zwarte mamba kun je dus zien als de dodelijkste slangensoort.

 © Shutterstock / Thorsten Spoerlein
Figuur 7 De pijlgifkikker levert dodelijk gif voor pijlpunten.
© Shutterstock / Ken Griffiths
Figuur 9 De westelijke taipan heeft het dodelijkste gif van alle slangen.
© Shutterstock / el_cigarrito
Figuur 8 De groene knolamaniet is de giftigste paddenstoel in Nederland.
© Shutterstock / NickEvansKZN
© Shutterstock / Thorsten Spoerlein
Figuur 7 De pijlgifkikker levert dodelijk gif voor pijlpunten.
© Shutterstock / Ken Griffiths
Figuur 9 De westelijke taipan heeft het dodelijkste gif van alle slangen.
© Shutterstock / el_cigarrito
Figuur 8 De groene knolamaniet is de giftigste paddenstoel in Nederland.
© Shutterstock / NickEvansKZN
67 Hoofdstuk 1 Waarom biologie? Verdieping: Extreme organismen 1.8
Figuur 10 De zwarte mamba is misschien het gevaarlijkst.
Wie is de snelste?
Sommige dieren blinken uit door hun snelheid. Ze zetten hun hoge snelheid in om prooien te vangen. Het snelste dier ter wereld kom je in Nederland tegen, zelfs in steden! Het gaat om de slechtvalk (zie figuur 11). Deze vogel kan meer dan 350 kilometer per uur vliegen. In het water is de zwarte marlijn het snelste (zie figuur 12). Deze vis kan een snelheid van 129 kilometer per uur bereiken. Op het land is de cheeta de snelste met een snelheid van 100 kilometer per uur (zie figuur 13).

Extreme organismen
Overal op aarde is leven, zelfs in extreme omstandigheden. Organismen die onder extreme omstandigheden leven noem je extremofielen. Vaak zijn dat bacteriën. Ze zijn aangepast aan een leefomgeving waar vrijwel alle andere organismen dood zouden gaan. Extremofielen komen voor in hete geisers en hete modderpoelen, bijvoorbeeld in IJsland en het Yellowstone National Park in de Verenigde Staten (zie figuur 14). Bepaalde bacteriesoorten groeien in een omgeving met een temperatuur van wel 120°C.

Er zijn ook bacteriën die goed kunnen groeien in heel koud water. Weer andere bacteriesoorten voelen zich thuis in verdund zwavelzuur (nog zuurder dan citroensap) of in zout water dat tien maal zo zout is als zeewater. Zulke bacteriën zijn misschien wel overblijfselen uit de tijd dat de omstandigheden overal op aarde heel extreem waren en het leven op aarde zich net begon te ontwikkelen. De aarde leek in die tijd op een onbewoonbare planeet in het heelal.
De bacteriesoort met de naam Clostridium botulinum is ook in staat tot iets extreems.


Deze maakt namelijk het giftigste gif ter wereld: botuline (zie figuur 15). Het is zo giftig dat je aan 0,00000003 gram per kilo lichaamsgewicht genoeg hebt om een mens te doden. Botuline tast je zenuwstelsel aan, waardoor je dood kunt gaan. Maar als je dit gif heel erg verdunt, kun je het gebruiken om van je rimpels af te komen. Botox is verdund botuline!
 © Shutterstock / Harry Collins Photography
Figuur 11 Slechtvalk, de snelste in de lucht
© Getty Images / iStock / VSpiller
© Shutterstock / Harry Collins Photography
Figuur 11 Slechtvalk, de snelste in de lucht
© Getty Images / iStock / VSpiller
© Shutterstock / Stu Porter
Figuur 12 Zwarte marlijn, de snelste in het water
© ANP / BSIP
Figuur 13 Cheeta, de snelste op het land
Figuur 15 Clostridium botulinum
68 Hoofdstuk 1 Waarom biologie? Verdieping: Extreme organismen 1.8
Figuur 14 De oranje rand van deze hete bron in Yellowstone Park wordt gevormd door extremofiele bacteriën.
OPDRACHTEN
2 De snelste dieren
De slechtvalk is het snelste dier in de lucht, de zwarte marlijn is het snelste dier in het water en de cheeta is het snelste dier op het land.
a Hoe snel kunnen deze dieren bewegen? Maak de juiste combinaties.
slechtvalk
zwarte marlijn
• • 100 km/uur
• • 129 km/uur
cheeta • • 350 km/uur
b Wat maakt dat deze dieren zo snel kunnen bewegen? Kijk hiervoor naar het uiterlijk van de dieren.
3 Recordhouders
Welke bewering is juist?
◯ Pijlgifkikkers zijn zo giftig doordat ze vaak met giftige pijlen worden beschoten.
◯ Sommige bacteriesoorten kunnen overleven bij 120°C.
◯ De weidechampignon is de giftigste paddenstoel in Nederland.
◯ De oudste vis die ooit is gevonden was 300 jaar oud.
4
Top 13
In de theorie van paragraaf 1.8 'Verdieping: Extreme organismen' zijn organismen beschreven die tot iets extreems in staat zijn.
a Welk organisme is naar jouw mening het meest extreem?
Zet de organismen op volgorde, met bovenaan het organisme dat volgens jou het meest extreem is. Noteer de cijfers 1 t/m 13 in de vakjes.
▢ Amerikaanse ratelpopulier
▢ bacteriesoort Clostridium botulinum
▢ westelijke taipan
▢ blauwe vinvis
▢ Bristlecone Pine
▢ cheeta
▢ groene knolamaniet
▢ Groenlandse haai
▢ pijlgifkikker
▢ reuzensequoia
▢ slechtvalk
▢ zwarte mamba
▢ zwarte marlijn
b Vergelijk jouw lijstje met dat van een klasgenoot en leg aan elkaar uit waarom je tot dit lijstje gekomen bent.
69 Hoofdstuk 1 Waarom biologie? Verdieping: Extreme organismen 1.8
5 Verrassende recordhouders
Sommige dieren zijn recordhouders in snelheid, afgelegde afstand, volume, massa, enzovoort.
Waarin zijn onderstaande organismen recordhouder? Maak de juiste combinaties.
Tip: Je mag internet gebruiken.
langst afgelegde afstand per jaar
giftigheid
• • grote plompe lori
• • luiaard
massa • • nano-kameleon
volume
snelheid
6 Beerdiertje
• • Noordse stern
• • struisvogel
Niet alle extremofielen zijn bacteriën. Het beerdiertje is geen bacterie, maar wel een extremofiel.
Tip: Bekijk het filmpje 'Hoe beweegt een beerdiertje?' en zoek aanvullende informatie over het beerdiertje op internet.
Maak een striptekening met in de hoofdrol een beerdiertje.
Laat in je striptekening naar voren komen tot welke extreme dingen het beerdiertje in staat is. En in welke extreme leefomgevingen hij kan voorkomen.
7 Records bij planten en dieren
Maak een presentatie met maximaal vijf dia’s over recordhouders bij planten en dieren die jij het meest indrukwekkend vindt. Lever de presentatie in bij je docent.
Laat in je presentatie het volgende zien of vertel erover:
• welk record deze soort bezit
• het ecosysteem waarin de soort voorkomt
• waar op aarde je de soort kunt vinden
• de leefwijze
• de voortplanting
70 Hoofdstuk 1 Waarom biologie? Verdieping: Extreme organismen 1.8
1.9 HOOFDSTUKAFSLUITING

ACTIEF LEREN
Hoe leer je de theorie en begrippen uit het hoofdstuk? En hoe leg je de juiste verbanden? Kies een opdracht uit Actief leren achter in je boek als hulp bij het leren.
TERUG NAAR HET GROTE PLAATJE
1 Waarom biologie?
Maak de cirkel rond. De leerling kijkt terug naar het grote plaatje. Wat heb je dit hoofdstuk geleerd? Hoe kijk jij naar het grote plaatje?
Je ziet hier nog een keer ‘het grote plaatje’ uit de hoofdstukopening.
a Je ziet links de verbanden tussen dit hoofdstuk en andere hoofdstukken.
Leg deze verbanden uit. Schrijf je antwoorden in de vakjes.
b Je ziet rechts iconen die laten zien waar het om draait in dit hoofdstuk.
Leg in je eigen woorden uit wat je ziet en wat je hebt geleerd in dit hoofdstuk. Schrijf je antwoorden in de vakjes.
c Je hebt in paragraaf 1 antwoord gegeven op de grote vraag 'Biologie, wat heb je eraan?'
Kijk nog even terug naar wat je toen hebt geantwoord.
Zou je je antwoord aanpassen na het doorlopen van dit hoofdstuk? Zo ja, wat zou je nu zeggen?
Betrek in je antwoord de verbanden en de punten waar het om draait uit het grote plaatje.
H
Biologie
Binnen
Biologie
Welke verbanden zijn er? Waar draait het in dit hoofdstuk om? Biologie, wat heb je eraan?
H 4 • Bewegen Botten en spieren H 2 • Inzoomen Cellen
3 • Leven op aarde Organismen
helpt je om eigen keuzes te maken
de biologie hangt alles samen
gaat over al het leven op aarde Biologisch onderzoek maakt nieuwe oplossingen mogelijk
H 7 • Jouw omgeving en duurzaamheid Leefomgeving
71 Hoofdstuk 1 Waarom biologie? Hoofdstukafsluiting 1.9
TERUG NAAR DE UITDAGING
Maak online je eindproduct bij de Uitdaging

PROEFTOETS
Maak online de proeftoets bij dit hoofdstuk.

LEERDOELEN
Online oefenen leerlingen met de Proeftoets. Die geeft gericht advies waar ze nog aan moeten werken voor de toets.
Kruis aan hoe goed je elk leerdoel beheerst. Nog niet alle leerdoelen gehaald? Neem de bijbehorende stof nog een keer door.
Reflecteren is essentieel in het leerproces. Hoe kijken leerlingen zelf naar de leerdoelen en hoe goed beheersen ze die?
Biologie, wat heb je eraan? Je kunt...
1 uitleggen waar biologie over gaat.
2 uitleggen welke onderwerpen in je eigen leven met biologie te maken hebben.
3 uitleggen hoe biologie samenhangt met andere vakken.
4 uitleggen waarom biologisch onderzoek voor jouw leven belangrijk is.
Levende wezens. Je kunt...
1 de zeven levenskenmerken benoemen.
2 uitleggen of iets levend, levenloos of dood is.

3 uitleggen wat biotische en abiotische factoren zijn en hoe deze van invloed zijn op organismen.
Verschillende organismen. Je kunt...
1 uitleggen in welke vier hoofdgroepen organismen ingedeeld worden.
2 van een organisme vertellen of dit een plant, dier, bacterie of schimmel is.
3 uitleggen dat er ‘goede’ en ‘slechte’ bacteriën zijn en van beide voorbeelden geven.
4 uitleggen dat er ‘goede’ en ‘slechte’ schimmels zijn en van beide voorbeelden geven.
◯ ◯ ◯ ◯
◯ ◯ ◯ ◯
◯ ◯ ◯ ◯
◯ ◯ ◯ ◯
◯ ◯ ◯ ◯
◯ ◯ ◯ ◯
◯ ◯ ◯ ◯
◯ ◯ ◯ ◯
◯ ◯ ◯ ◯
◯ ◯ ◯ ◯
◯ ◯ ◯ ◯
72 Hoofdstuk 1 Waarom biologie? Hoofdstukafsluiting 1.9
Organismen en hun omgeving. Je kunt...
1 uitleggen dat organismen aan hun omgeving aangepast zijn.
2 benoemen wat een soort is in de biologie.
3 verschillende samenlevingsvormen van organismen noemen.
4 uitleggen hoe verschillende soorten organismen samenwerken en/of van elkaar afhankelijk zijn.
Alles hangt samen. Je kunt...
1 uitleggen dat je de natuur op verschillende niveaus kunt bekijken.
2 uitleggen hoe deze niveaus met elkaar samenhangen.
3 uitleggen wat een ecosysteem is en voorbeelden noemen.
4 uitleggen wat een voedselkringloop is en voorbeelden noemen.
Biologisch onderzoek. Je kunt...
1 uitleggen uit welke stappen een natuurwetenschappelijk onderzoek bestaat.
2 uitleggen hoe je resultaten van een onderzoek overzichtelijk kunt weergeven in een tabel of diagram.
◯ ◯ ◯ ◯
◯ ◯ ◯ ◯
◯ ◯ ◯ ◯
◯ ◯ ◯ ◯
◯ ◯ ◯ ◯
◯ ◯ ◯ ◯
◯ ◯ ◯ ◯
◯ ◯ ◯ ◯
◯ ◯ ◯ ◯
◯ ◯ ◯ ◯ 73 Hoofdstuk 1 Waarom biologie? Hoofdstukafsluiting 1.9




















































































































































































































































 © Shutterstock / Marek Mierzejewski
De boskikker bevriest in de winter en ontdooit in de lente.
© Shutterstock / Marek Mierzejewski
De boskikker bevriest in de winter en ontdooit in de lente.





















 © Shutterstock / divedog
© Shutterstock / JAZ STUDIO
Figuur 7 Verschillende soorten planten
© Getty Images / iStock / NajaShot
Figuur 6 Een heksenkring is een cirkel van paddenstoelen.
© Shutterstock / nyker
© Shutterstock / divedog
© Shutterstock / JAZ STUDIO
Figuur 7 Verschillende soorten planten
© Getty Images / iStock / NajaShot
Figuur 6 Een heksenkring is een cirkel van paddenstoelen.
© Shutterstock / nyker



 © Shutterstock / Thorsten Schier
Figuur 8 Speenkruid bloeit in de lente.
© Getty Images / E+ / Nancy Nehrin
Figuur 9 Microscopische foto van het pantoffeldiertje, een eencellig dier
© Shutterstock / 3Dstock
Figuur 10 Microscopische foto van het beerdiertje, één van de kleinste meercellige dieren
© WESTON, J.N.J. et al. 2020
© Shutterstock / Thorsten Schier
Figuur 8 Speenkruid bloeit in de lente.
© Getty Images / E+ / Nancy Nehrin
Figuur 9 Microscopische foto van het pantoffeldiertje, een eencellig dier
© Shutterstock / 3Dstock
Figuur 10 Microscopische foto van het beerdiertje, één van de kleinste meercellige dieren
© WESTON, J.N.J. et al. 2020















 Figuur 1 De sneeuwuil leeft in het noordelijk poolgebied.
©
Getty Images / iStock / RobChris
Figuur 2 De bosuil leeft onder andere in Nederland.
© Shutterstock / Dominyk Lever
Figuur 3 De tweehoornkameleon is goed aangepast aan zijn omgeving.
© Shutterstock / Bouke Atema
Figuur 1 De sneeuwuil leeft in het noordelijk poolgebied.
©
Getty Images / iStock / RobChris
Figuur 2 De bosuil leeft onder andere in Nederland.
© Shutterstock / Dominyk Lever
Figuur 3 De tweehoornkameleon is goed aangepast aan zijn omgeving.
© Shutterstock / Bouke Atema


 ©
Shutterstock / Jim Cumming
Figuur 5 Een grijze wolf en een poedel
© Shutterstock / Anna_Bondarenko
© Imageselect / Paulo de Oliveira
©
Shutterstock / Jim Cumming
Figuur 5 Een grijze wolf en een poedel
© Shutterstock / Anna_Bondarenko
© Imageselect / Paulo de Oliveira


 © Getty Images / iStock / mtreasur
Figuur 7 Egel met teken. Sommige teken zijn besmet met bacteriën.
© Getty Images / iStock / mtreasur
Figuur 7 Egel met teken. Sommige teken zijn besmet met bacteriën.



















 planten
planteneters
en bacteriën
planten
planteneters
en bacteriën

© Shutterstock / Thorsten Spoerlein
Figuur 7 De pijlgifkikker levert dodelijk gif voor pijlpunten.
© Shutterstock / Ken Griffiths
Figuur 9 De westelijke taipan heeft het dodelijkste gif van alle slangen.
© Shutterstock / el_cigarrito
Figuur 8 De groene knolamaniet is de giftigste paddenstoel in Nederland.
© Shutterstock / NickEvansKZN
© Shutterstock / Thorsten Spoerlein
Figuur 7 De pijlgifkikker levert dodelijk gif voor pijlpunten.
© Shutterstock / Ken Griffiths
Figuur 9 De westelijke taipan heeft het dodelijkste gif van alle slangen.
© Shutterstock / el_cigarrito
Figuur 8 De groene knolamaniet is de giftigste paddenstoel in Nederland.
© Shutterstock / NickEvansKZN




 © Shutterstock / Harry Collins Photography
Figuur 11 Slechtvalk, de snelste in de lucht
© Getty Images / iStock / VSpiller
© Shutterstock / Harry Collins Photography
Figuur 11 Slechtvalk, de snelste in de lucht
© Getty Images / iStock / VSpiller






